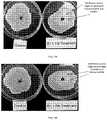

US11434415B2 - Compositions and methods for paraffin liquefaction and enhanced oil recovery in oil wells and associated equipment - Google Patents
Compositions and methods for paraffin liquefaction and enhanced oil recovery in oil wells and associated equipmentDownload PDFInfo
- Publication number
- US11434415B2 US11434415B2US17/052,181US201917052181AUS11434415B2US 11434415 B2US11434415 B2US 11434415B2US 201917052181 AUS201917052181 AUS 201917052181AUS 11434415 B2US11434415 B2US 11434415B2
- Authority
- US
- United States
- Prior art keywords
- oil
- paraffin
- composition
- formation
- yeast
- Prior art date
- Legal status (The legal status is an assumption and is not a legal conclusion. Google has not performed a legal analysis and makes no representation as to the accuracy of the status listed.)
- Active
Links
- 0[Y][Y][Y][1*]O[2*][Y][Y][Y][Y][Y][Y][Y]Chemical compound[Y][Y][Y][1*]O[2*][Y][Y][Y][Y][Y][Y][Y]0.000description1
Images
Classifications
- C—CHEMISTRY; METALLURGY
- C09—DYES; PAINTS; POLISHES; NATURAL RESINS; ADHESIVES; COMPOSITIONS NOT OTHERWISE PROVIDED FOR; APPLICATIONS OF MATERIALS NOT OTHERWISE PROVIDED FOR
- C09K—MATERIALS FOR MISCELLANEOUS APPLICATIONS, NOT PROVIDED FOR ELSEWHERE
- C09K8/00—Compositions for drilling of boreholes or wells; Compositions for treating boreholes or wells, e.g. for completion or for remedial operations
- C09K8/58—Compositions for enhanced recovery methods for obtaining hydrocarbons, i.e. for improving the mobility of the oil, e.g. displacing fluids
- C09K8/582—Compositions for enhanced recovery methods for obtaining hydrocarbons, i.e. for improving the mobility of the oil, e.g. displacing fluids characterised by the use of bacteria
- C—CHEMISTRY; METALLURGY
- C09—DYES; PAINTS; POLISHES; NATURAL RESINS; ADHESIVES; COMPOSITIONS NOT OTHERWISE PROVIDED FOR; APPLICATIONS OF MATERIALS NOT OTHERWISE PROVIDED FOR
- C09K—MATERIALS FOR MISCELLANEOUS APPLICATIONS, NOT PROVIDED FOR ELSEWHERE
- C09K8/00—Compositions for drilling of boreholes or wells; Compositions for treating boreholes or wells, e.g. for completion or for remedial operations
- C09K8/58—Compositions for enhanced recovery methods for obtaining hydrocarbons, i.e. for improving the mobility of the oil, e.g. displacing fluids
- C09K8/584—Compositions for enhanced recovery methods for obtaining hydrocarbons, i.e. for improving the mobility of the oil, e.g. displacing fluids characterised by the use of specific surfactants
- C—CHEMISTRY; METALLURGY
- C09—DYES; PAINTS; POLISHES; NATURAL RESINS; ADHESIVES; COMPOSITIONS NOT OTHERWISE PROVIDED FOR; APPLICATIONS OF MATERIALS NOT OTHERWISE PROVIDED FOR
- C09K—MATERIALS FOR MISCELLANEOUS APPLICATIONS, NOT PROVIDED FOR ELSEWHERE
- C09K8/00—Compositions for drilling of boreholes or wells; Compositions for treating boreholes or wells, e.g. for completion or for remedial operations
- C09K8/52—Compositions for preventing, limiting or eliminating depositions, e.g. for cleaning
- C09K8/524—Compositions for preventing, limiting or eliminating depositions, e.g. for cleaning organic depositions, e.g. paraffins or asphaltenes
- E—FIXED CONSTRUCTIONS
- E21—EARTH OR ROCK DRILLING; MINING
- E21B—EARTH OR ROCK DRILLING; OBTAINING OIL, GAS, WATER, SOLUBLE OR MELTABLE MATERIALS OR A SLURRY OF MINERALS FROM WELLS
- E21B43/00—Methods or apparatus for obtaining oil, gas, water, soluble or meltable materials or a slurry of minerals from wells
- E21B43/16—Enhanced recovery methods for obtaining hydrocarbons
- C—CHEMISTRY; METALLURGY
- C09—DYES; PAINTS; POLISHES; NATURAL RESINS; ADHESIVES; COMPOSITIONS NOT OTHERWISE PROVIDED FOR; APPLICATIONS OF MATERIALS NOT OTHERWISE PROVIDED FOR
- C09K—MATERIALS FOR MISCELLANEOUS APPLICATIONS, NOT PROVIDED FOR ELSEWHERE
- C09K2208/00—Aspects relating to compositions of drilling or well treatment fluids
- C09K2208/32—Anticorrosion additives
Definitions
- problematic depositscan be formed by, for example, high-molecular-weight constituents of petroleum fluids, most notably, paraffins and asphaltenes, as well as bacterial deposits, often in the form of biofilms.
- Paraffin depositsin particular, can range from soft accumulations of lighter-molecular-weight paraffins to hard and/or brittle accumulations as the molecular weight of the paraffin increases. Paraffin deposition is primarily a result of a loss in solubility of certain components in the crude oil, which can be caused by a decrease in temperature or pressure in an oil well or formation.
- Temperature decreasecan be caused by, for example, expansion of gas through perforations and from the lifting of fluids to the earth surface; radiation of heat from tubing into the surrounding formation; intrusion of water into or around the wellbore; vaporization-induced loss of lighter constituents in the crude oil; and/or recovery and transport of oil during winter months or in climates that are cold year-round. Additionally, in offshore operations, decrease in temperature can occur when crude oil enters subsea pipelines, which can have temperatures as low as 4° C.
- the “pour point” and the “cloud point”are two physical properties of liquid fuels that can also contribute to the precipitation of dissolved solids such as paraffins in crude fluids, as well as the ability of crude fluids to flow through pipelines and tubulars.
- Cloud pointor, Wax Appearance Temperature
- dissolved solids present in the cruderemain soluble, but below the cloud point, they start to precipitate and create a cloudy appearance. This is an indicator of how well the fuel will perform under cold weather conditions, because, not only can wax clog equipment, but it can also deposit onto pipelines and other equipment surfaces.
- Pour pointis the lowest temperature at which the flow or movement of oil, i.e., the ability of the oil to be pumped, is still possible. Below this temperature, the crude stops flowing and starts to crystallize and/or freeze. Highly paraffinic crude oils have higher pour point values.
- Paraffin that remains entrained in crude oildoes not typically cause issues in production. It is when the paraffin particles precipitate and begin to accumulate as solid or semi-solid deposits that the most significant problems related to paraffin occur.
- the presence of water on the formation pore walls or on tubing inner surfaces, as well as the quality and smoothness of pipescan inhibit deposition; however rusty pipes with rough surfaces will encourage deposition.
- upkeep of equipment surfacesis important for prevention of paraffin depositions.
- minimizing the cooling of the crude oil as it is brought to the surface, using, for example specially designed pumping wells and tubingcan aide in prevention of paraffin depositions.
- Paraffin inhibitor chemicalswhich are a class of compounds that typically consist of crystal modifiers that prevent the deposition of paraffin onto surfaces, can also be used. These surface-active materials inhibit the adhesion of paraffin to sites on, e.g., the tubing walls; however, the efficacy of any given inhibitor chemical depends upon the specific composition of the crude oil within the well, which can be highly variable depending on, for example, the geographical location. Other methods of inhibition, involving plastic coatings on tubulars, and electrical heaters, can be extremely costly, and thus are limited.
- Mechanical removaltypically involves the use of scrapers or cutters to physically remove deposits. For example, in tanks where precipitation has occurred, the sides of the tank must be cut out and force, e.g., a sledgehammer, is then used to remove the deposits. For pipelines, complete replacement of pipes is often required if deposits become too thick for manual or mechanical removal.
- Chemical removalinvolves the use of solvents or surfactants that can solubilize deposits or interfere with their crystallization and formation.
- solventsinclude benzene, toluene and xylene.
- microbial methodscertain strains of bacteria can be used to degrade deposits themselves, or can produce natural biochemicals that do so.
- Biofilmscan also build up in various structures and processing mechanisms, including shale formation facing, wells, pipes, and tanks.
- “Biofilm”comprises layers of biomass made up of a compact grouping of microorganisms surrounded by an extracellular matrix of polymeric substances. Biofilms adhere to surfaces of many man-made mechanisms, such as tubes and pipes, and can significantly impair their proper functioning. Additionally, many of the biofilms present in, or on, oil rigs contain sulfate-reducing bacteria that generate potent chemical byproducts, e.g., hydrogen sulfide. Hydrogen sulfide gas is harmful for drill workers who might breathe it.
- hydrogen sulfidecan cause corrosion of various mechanisms within an oil producing structure (known as “microbial induced corrosion” or “MIC”) and can cause the souring of oil during storage or transport.
- MICmicrobial induced corrosion
- Sour oilcontains a high sulfur content, which increases costs for producers and consumers due to the increase of time and resources required for processing the oil.
- the subject inventionprovides compositions and methods for improving oil well performance by removing paraffin deposits from oil- and/or natural gas-bearing formations, and/or the wells and production equipment associated therewith, as well as for enhancing oil recovery.
- materials and methodsare provided for improving oil and/or gas production by liquefying or dissolving solid paraffin deposits and dispersing and/or emulsifying precipitated paraffin back into crude oil.
- the paraffinremains dispersed in the oil after treatment and does not re-precipitate.
- the subject inventionprovides a composition for improving oil and/or gas production, the composition comprising one or more solvents and one or more surfactants.
- the compositioncomprises one or more solvents, one or more surfactants, one or more yeast fermentation products, one or more chelating agent(s), and, optionally, one or more ammonium salts and/or co-surfactants.
- the solvent(s) and/or the surfactant(s)can be produced by non-biological means (e.g., chemical isolation, purification and/or synthesis).
- the solvents and/or surfactantscan be derived from natural or biological sources, such as, for example, the living cells of microorganisms, plants, fungi and/or animals.
- the compositioncan further comprise one or more yeast fermentation products.
- a yeast fermentation productcomprises a yeast strain, such as, for example, Wickerhamomyces anomalus, Starmerella bombicola , or Meyerozyma guilliermondii , and/or by-products produced during cultivation of the yeast.
- the yeast cellsare thermally inactivated before being added to the composition.
- yeast fermentation products according to the subject inventioncan be superior to, for example, purified microbial metabolites alone, due to, for example, the advantageous properties of the yeast cell walls.
- These propertiesinclude high concentrations of mannoprotein as a part of yeast cell wall's outer surface (mannoprotein is a highly effective bioemulsifier) and the presence of biopolymer beta-glucan (also an effective emulsifier) in yeast cell walls.
- the yeast fermentation productfurther can comprise biosurfactants capable of reducing both surface and interfacial tension, enzymes capable of solubilizing heavy hydrocarbon and/or paraffinic compounds, and other metabolites (e.g., lactic acid, ethyl acetate, ethanol, etc.), in the culture.
- certain fungiother than yeasts, have cell walls containing the same advantageous properties. Accordingly, fermentation products comprising non-yeast fungi can also be used according to the subject invention.
- a first yeast fermentation productdesignated as “Star 3+,” can be obtained via cultivation of a yeast, e.g., Wickerhamomyces anomalus , using a modified form of solid state fermentation.
- the culturecan be grown on a substrate with ample surface area onto which the yeasts can attach and propagate, such as, for example, corn flour, rice, soybeans, chickpeas, pasta, oatmeal or beans.
- the entire fermentation medium with yeast cells growing throughout, and any growth by-products thereofe.g., enzymes, solvents, and/or biosurfactants
- any growth by-products thereofe.g., enzymes, solvents, and/or biosurfactants
- the culturecan be washed out and used in liquid form, or blended with the solid substrate, milled and/or micronized, and optionally, dried. This comprises the Star 3+ product.
- the productcan be diluted in oil, water and/or brine fluids, for example, 5 to 1,000 times, prior to being added to the composition.
- the first yeast fermentation product(e.g., Star 3+) is obtained using submerged fermentation, wherein the first yeast fermentation product comprises liquid broth comprising water, cells and any yeast growth by-products.
- the composition according to the subject inventioncomprises one or more solvents.
- the one or more solventsare not produced by the yeasts of the first yeast fermentation product, meaning they are present in addition to any solvents that may happen to be present in the first yeast fermentation product.
- the one or more solventsare non-polar aromatic solvents.
- the solventscan include one or more of, for example, terpenes, terpenoids, acetates, ionic or semi-ionic liquids, alcohols, kerosene, gasoline, diesel, benzene, toluene, and/or xylene.
- the one or more solventscan include naturally-derived acetates, such as, for example, isoamyl acetate and/or primary amyl acetate.
- the one or more solventscan include terpenes and/or terpenoids, such as, for example, turpentine, dipentene and/or D-limonene.
- the one or more solventscan include alcohols, such as hexanol and/or isopropyl alcohol.
- the one or more solventscan include an ionic or semi-ionic liquid, for example, a semi-ionic liquid comprising a mixture of glycerol and Epsom salt (MgSO 4 .7H 2 O).
- an ionic or semi-ionic liquidfor example, a semi-ionic liquid comprising a mixture of glycerol and Epsom salt (MgSO 4 .7H 2 O).
- any combination of these solventsis utilized with one or more surfactants.
- the compositionis customized based on the type of paraffin that is present in a well. For example, paraffin deposits can vary from soft accumulations to hard, brittle, solidified deposits. Thus, in some embodiments, the concentration of solvent in the composition can be increased (e.g., up to about 10% of the composition) to boost the dispersal capabilities when harder paraffins are present.
- the compositioncomprises one or more surfactants, which, along with paraffin removal and/or dispersal, can provide additional enhanced oil recovery.
- the surfactant(s)can be of non-biological origin and/or they can be biosurfactants, meaning surfactants produced by a living cell.
- Non-biological surfactantscan be selected from, for example, anionic, cationic, zwitterionic and/or nonionic classes of surfactants.
- the one or more surfactantsare biosurfactants.
- the one or more biosurfactantsare not produced by the yeasts of the first yeast fermentation product, meaning they are included in the composition in addition to any biosurfactants that may be present in the first yeast fermentation product.
- the biosurfactantscan be added to the composition in purified form and/or in crude form.
- the biosurfactantcan be added to the composition in the form of a microbial culture, e.g., a second yeast fermentation product, containing liquid fermentation broth and cells resulting from submerged cultivation of a biosurfactant-producing microbe, e.g., Wickerhamomyces anomalus, Starmerella bombicola or Meyerozyma guilliermondii.
- Biosurfactants useful according to the subject inventioninclude, for example, low-molecular-weight glycolipids, cellobiose lipids, lipopeptides, fatty acid esters, fatty acid ethers, flavolipids, phospholipids, and high-molecular-weight polymers/biopolymers such as lipoproteins, lipopolysaccharide-protein complexes, and/or polysaccharide-protein-fatty acid complexes.
- the biosurfactantscan comprise one or more glycolipids such as, for example, rhamnolipids (RLP), rhamnose-d-phospholipids, trehalose lipids, trehalose dimycolates, trehalose monomycolates, mannosylerythritol lipids (MEL), cellobiose lipids, ustilagic acids and/or sophorolipids (SLP) (including lactonic forms and/or acidic forms).
- RLPrhamnolipids
- MELmannosylerythritol lipids
- SLPsophorolipids
- the biosurfactantscan comprise one or more lipopeptides, such as, for example, surfactin, iturin, fengycin, arthrofactin, viscosin, amphisin, syringomycin, and/or lichenysin.
- the biosurfactantscan comprise one or more fatty acid esters and/or one or more fatty acid ethers.
- the biosurfactantscan comprise one or more other types of biosurfactants, such as, for example, cardiolipin, emulsan, lipomanan, alasan, and/or liposan.
- the surfactantscan comprise one or more microbial compounds having physical properties and/or behaviors similar to those of biosurfactants, but which are not commonly known as biosurfactants. These compounds can be fatty acid esters and/or fatty acid ethers. In certain embodiments, the fatty acid compounds can comprise carbon chains with 6 to 22 carbon atoms. In certain embodiments, the fatty acid(s) of the fatty acid compounds is unsaturated.
- the compositionfurther comprises one or more chelating agents, for example, EDTA, citric acid, citrate, sodium acetate, or a mixture thereof.
- the chelating agentis sodium citrate.
- the subject compositioncan further comprise carriers (e.g., water, oil and/or brine fluids) as well as other compounds that are useful for paraffin removal and/or enhanced oil recovery, such as, for example, ammonium salts, co-surfactants, and/or enzymes (e.g., extracellular enzymes derived from Aspergillus spp.), These additional compounds can be added at concentrations ranging from, for example, about 0.001% to 50%, about 1% to 25%, or about 10%, by weight or volume.
- carrierse.g., water, oil and/or brine fluids
- other compounds that are useful for paraffin removal and/or enhanced oil recoverysuch as, for example, ammonium salts, co-surfactants, and/or enzymes (e.g., extracellular enzymes derived from Aspergillus spp.)
- additional compoundscan be added at concentrations ranging from, for example, about 0.001% to 50%, about 1% to 25%, or about 10%, by weight or volume.
- compositions of the subject inventionare shelf stable for at least one week or longer, and can be transported, stored and then applied selectively to an oil well at any point, for example, after a decline in production is observed.
- the subject inventionprovides methods of improving oil and/or gas production, wherein a composition according to the subject invention is applied to a subterranean formation, an oil and/or gas well, a wellbore, and/or equipment associated therewith.
- the methodsimprove the efficiency of oil and/or gas recovery by, e.g., decreasing the amount of resources and energy required to recover oil and/or gas from a formation, and in general, increasing the amount of oil and/or gas recovered over a certain period of time.
- the methodsimprove oil and/or natural gas (hereinafter, “gas”) production through the removal and dispersal of paraffin deposits and/or precipitates that have accumulated in a subterranean formation, in an oil and/or gas well, in a wellbore and/or in production equipment associated with any of these.
- gasoil and/or natural gas
- the methodsare useful for removing paraffin deposits from the rock pores of subterranean formations, from wells, wellbores, and from equipment, such as, for example, tubing, pipes, drills and tanks associated with all aspects of oil and/or gas production.
- the methodsprovide for recovery of economically valuable paraffin hydrocarbons by dispersing and/or emulsifying the dislodged paraffin back into crude oil fluids.
- applying the subject compositionalso helps inhibit paraffin deposition, and helps prevent re-deposition of dispersed paraffins while pumping and transporting.
- the compositioncan be customized for a particular well.
- the methodcomprises testing the well and/or associated equipment, analyzing the paraffin composition present therein and determining the ideal formulation for the composition prior to treatment.
- the subject methodscan be useful for removal and dispersal of a broad spectrum of paraffin types, including short chain paraffins and long chain paraffins.
- the methodsalso enhance oil recovery through, for example, the amphiphilic properties of surfactants, including biosurfactants.
- the subject methodscan also be useful for a multitude of other benefits related to oil and gas recovery, including, for example: inhibition of paraffin crystallization and prevention of paraffin deposition; reduction in viscosity of paraffinic crude oil; reduction in pour point of paraffinic crude oil (e.g., to about ⁇ 25° F./ ⁇ 32° C.); removal and/or dissolution of scale; release of rust from oilfield casings and related equipment; protection against under-deposit rust-related corrosion of equipment; inhibition of bacterial growth and disruption of biofilm formation on equipment; protection against microbial induced corrosion (MIC); alteration of the wettability of the near-wellbore surface to water-wet; and remediation of formation skin damage.
- MICmicrobial induced corrosion
- the subject methodscan be used alongside and/or to enhance or supplement other methods of paraffin removal/dispersal and/or enhanced oil recovery, e.g., other microbial, mechanical, thermal and/or chemical treatments.
- the methodcan be used to replace dangerous high heat steaming or oiling methods commonly used for paraffin removal.
- thermal, steaming and/or hot oil methodsare used, the present method can be used alongside (before, during or after) the thermal, steaming and/or hot oil to prevent recrystallization of the liquefied paraffins that are dispersed in the oil.
- the subject methodscomprise a chemical treatment for removing paraffin deposits present, for example, at or near a wellbore.
- the chemical treatment methodcan comprise applying a composition that comprises one or more chemical solvents and one or more non-biological surfactants to the wellbore.
- the combination of solvents with surfactantswhen compared to using, for example, solvents alone, can also provide enhanced oil recovery in addition to effectively dispersing paraffin back into crude oil fluids.
- this chemical treatmentdoes not require large volumes of treatment mixture, as is required for treating deep into a subterranean formation.
- the surfactantscan comprise, for example, from 1% to 50% of the volume of the chemical treatment, from 2% to 20%, or from 5% to 10%.
- the subject methodscan be utilized alongside and/or in combination with enzyme treatments for removal of hydrocarbon deposits and/or enhanced oil recovery, e.g., extracellular enzymes derived from Aspergillus spp.
- the subject inventioncan be used for improving, enhancing, and/or maintaining oil recovery from, and operation of, subterranean formations, oil and/or gas wells, boreholes, tubes, pipes, drills, tanks and other structures and equipment involved in oil and/or gas production, transportation, storage and refining.
- the subject inventioncan be used in, for example, vertical, horizontal and/or fracking wells, mature wells, stripper (marginal) wells, flowlines, to clean near wellbore zones and to clean storage tanks.
- application of a composition of the subject inventioncan be performed during drilling operations (e.g., while drilling, while tripping-in or tripping-out of the hole, while circulating mud, while casing, while placing a production liner, and/or while cementing, etc.), and/or as a production treatment (e.g., after oil and/or gas recovery is underway).
- the methodsare implemented once the rate of oil production from the well has begun to decline and/or at some point thereafter.
- the subject compositions and methodscan free stuck or floating rods, allowing inoperable wells to resume operation.
- the subject treatmentscan open up channels and pores/pore throats that are clogged with paraffin deposits and the adhesive/cohesive matrices that form when scale, polymers, sand, and other materials become lodged in the paraffin, thus allowing for improved oil production.
- the subject treatmentsrequire lower frequencies of application when compared to other conventional paraffin treatment methods.
- the subject inventioncan be utilized in recovery and transport of oil in locations where lower temperatures might cause paraffin deposition, such as, for example, in offshore wells, in the arctic or Antarctic, and in climates that experience cold winter temperatures.
- the subject inventioncan be utilized in oil wells with high formation water salinity levels.
- the compositionscan be useful in geologic regions where formation water salinity is up to 250,000 ppm (total dissolved solids), up to 300,000 ppm, or even up to 400,000 ppm or more.
- compositionscan be useful in treating mature wells and wells that have undergone hot oiling, as well as for removal of short- and long-chain paraffin deposits, including those that are particularly difficult to remove due to, for example, the heaviness, thickness and/or the hardness of the deposit.
- the subject compositions and methodscan be used without releasing large quantities of inorganic compounds into the environment. Additionally, the compositions and methods can utilize components, such as biosurfactants, that are biodegradable and toxicologically safe. Thus, while the subject invention can utilize non-biological or synthetic chemical components, the present invention can also be formulated as an environmentally-friendly treatment.
- FIG. 1shows pour point test tube treatment of paraffin with a composition according to one embodiment of the subject invention.
- the bottom of the test tubecontains a sold paraffin portion (denoted by the dashed arrow), which became solid at ⁇ 3° C. and did not flow upon tilting the test tube.
- D-limonene and canola oilseparated from the solution while the mixture was being chilled and remained liquid (denoted by the solid arrow).
- FIGS. 2A-2Bshow dispersal of a hard paraffin after 2 hours and 4 hours with two formulations of a composition according to embodiments of the subject invention.
- the formulation used in (B)comprised double the amount of solvent that the formulation used in (A) comprises.
- FIGS. 3A-3Bshow dispersal of a hard paraffin after 1 hour using a composition according to one embodiment of the subject invention (A), as compared to other treatments (B) (water, pentane, xylene, kerosene, condensate).
- FIGS. 4A-4Bshow dispersal of a hard paraffin after 2 hours using a composition according to one embodiment of the subject invention (A), as compared to other treatments (B) (water, pentane, xylene, kerosene, condensate).
- FIGS. 5A-5Bshow dispersal of a hard paraffin after 1 hour using a composition according to one embodiment of the subject invention (A), as compared to other treatments (B) (water, pentane, xylene, kerosene, condensate).
- FIGS. 6A-6Bshow a segment of corroded casing from an oil well in the Appalachian region before treatment (A) and after treatment (B) with a composition according to one embodiment of the subject invention. As shown, the amount of rust on the segment was reduced after 16 hours of soaking in the subject composition.
- FIGS. 7A-7Bshow (A) Gram-positive and (B) Gram-negative bacterial inhibition in CFU/ml over time after treatment with a composition according to one embodiment of the subject invention.
- the darkest, highest lineindicates the normal growth of the respective bacteria (control).
- FIGS. 8A-8Cshow a comparison of biofilm formation inhibition with direct treatment with 1% (A), 5% (B) and 10% v/v (C) dilutions of the subject composition versus control, untreated biofilm.
- Direct treatmentinvolved adding a composition according to one embodiment of the subject invention directly to the surface of the bacteria.
- FIGS. 9A-9Cshow a comparison of biofilm formation inhibition with indirect treatment with 1% (A), 5% (B) and 10% v/v (C) dilutions of a composition according to one embodiment of the subject invention versus control, untreated biofilm.
- Indirect treatmentinvolved removing a section of agar from a plate where bacterial culture was spread and dried, injecting the composition into the voided space in the agar, and allowing the composition to soak into the agar.
- FIGS. 10A-10Bshow the effect of a composition according to one embodiment of the subject invention on disrupting established biofilm (B) versus untreated control (A). Within 16 hours of treatment, the initial signs of biofilm degradation could be observed.
- the subject inventionprovides compositions and methods for improving oil well performance by removing paraffin deposits from oil- and/or natural gas-bearing formations, and/or the wells and production equipment associated therewith, as well as for enhancing oil recovery.
- materials and methodsare provided for improving oil and/or gas production by liquefying or dissolving solid paraffin deposits and dispersing and/or emulsifying precipitated paraffin back into crude oil.
- the paraffinremains dispersed in the oil after treatment and does not re-precipitate.
- the subject methodscan also be useful for a multitude of other benefits related to oil and gas recovery, including, for example: inhibition of paraffin deposition; release of rust from oilfield casings and related equipment; protection against under-deposit rust-related corrosion of equipment; inhibition of bacterial growth and disruption of biofilm formation on equipment; protection against microbial induced corrosion (MIC); reduction in viscosity of paraffinic crude oil; reduction in pour point of paraffinic crude oil (e.g., to about ⁇ 25° F./ ⁇ 32° C.); removal and/or dissolution of scale; alteration of the wettability of the near-wellbore surface to water-wet; and remediation of formation skin damage.
- MICmicrobial induced corrosion
- contaminantrefers to any substance that causes another substance or object to become fouled or impure. Contaminants can be living or non-living and can be inorganic or organic substances and/or deposits. Furthermore, contaminants can include, but are not limited to, hydrocarbons, such as petroleum, tar sands or asphaltenes; fats, oils and greases (FOG), such as cooking grease and lard; lipids; waxes, such as paraffin; resins; biofilms; or any other substances referred to as, for example, dirt, dust, scale (including calcium carbonate, calcium chloride, barium carbonate, barium chloride, and iron sulfide), sludge, crud, slag, grime, scum, plaque, buildup, or residue.
- hydrocarbonssuch as petroleum, tar sands or asphaltenes
- FOGfats, oils and greases
- lipidssuch as cooking grease and lard
- waxessuch as paraffin
- resinssuch as paraffin
- the contaminantis paraffin.
- paraffinsinclude any wax-like organic hydrocarbon precipitate belonging to the alkane group and having a general formula of C n H 2n+2 . They can include normal, branched or cyclic alkanes. Further, they can include shorter chain (e.g., 20 carbons) to longer chain (e.g., 40 carbons or more) paraffins.
- deposited paraffinalso contains mixtures of gums, resins, asphaltic material, polymers, crude oil, scale, sand, silt, water and other formation substances. They vary in consistency from a mushy liquid to a firm hard wax, depending upon, for example, the amount and type of oil present, the temperature, and the age of the deposit.
- removalas used in the context of contaminants or fouling means elimination or reduction of contaminants from a surface, a space or a piece of equipment. Removal can include purifying, defouling, decontaminating, clearing or unclogging, and can be achieved by any means, including but not limited to, liquefying, dissolving, melting, dispersing, emulsifying, scraping, degrading, blasting, soaking, or cleaving the contaminant. Furthermore, removal can be total or partial.
- preventionmeans avoiding, delaying, forestalling, inhibiting or minimizing the onset or progression of an occurrence or situation.
- Preventioncan include, but does not require, absolute or complete prevention, meaning the occurrence or situation may still develop, but at a later time than it would without preventative measures.
- Preventioncan also include reducing the severity and/or extensiveness of an occurrence or situation, and/or inhibiting the progression in severity and/or extensiveness.
- the subject inventioncan be useful for preventing the deposition and/or re-deposition of paraffin onto a surface.
- microbe-based compositionmeans a composition that comprises components that were produced as the result of the growth of microorganisms or other cell cultures.
- the microbe-based compositionmay comprise the microbes themselves and/or products of microbial growth.
- the microbesmay be in a vegetative state, in spore form, in mycelial form in any other form of propagule, or a mixture of these.
- the microbesmay be planktonic or in a biofilm form, or a mixture of both.
- the products of growthmay be, for example, metabolites, cell membrane components, expressed proteins, and/or other cellular components.
- the microbesmay be intact or lysed; active or inactive.
- the microbesare present, with medium in which they were grown, in the microbe-based composition.
- the microbesmay be removed from the composition, or they may be present at, for example, a concentration of at least 1 ⁇ 10 4 , 1 ⁇ 10 5 , 1 ⁇ 10 6 , 1 ⁇ 10 7 , 1 ⁇ 10 8 , 1 ⁇ 10 9 , 1 ⁇ 10 10 , 1 ⁇ 10 11 , 1 ⁇ 10 12 , or 1 ⁇ 10 13 or more propagules per milliliter of the composition.
- a propaguleis any portion of a microorganism from which a new and/or mature organism can develop, including but not limited to, cells, spores (e.g., reproductive spores, endospore and exospores), mycelia, cysts, conidia, buds and seeds.
- sporese.g., reproductive spores, endospore and exospores
- myceliae.g., mycelia, cysts, conidia, buds and seeds.
- the subject inventionfurther provides “microbe-based products,” which are products that are to be applied in practice to achieve a desired result.
- the microbe-based productcan be simply the microbe-based composition harvested from the microbe cultivation process.
- the microbe-based productmay comprise further ingredients that have been added, or it may have ingredients removed therefrom. Additional ingredients can include, for example, stabilizers, buffers, appropriate carriers, such as water, salt solutions, or any other appropriate carrier, added nutrients to support further microbial growth, non-nutrient growth enhancers, such as plant hormones, and/or agents that facilitate tracking of the microbes and/or the composition in the environment to which it is applied.
- the microbe-based productmay also comprise mixtures of microbe-based compositions.
- the microbe-based productmay also comprise one or more components of a microbe-based composition that have been processed in some way such as, but not limited to, filtering, centrifugation, lysing, drying, purification and the like.
- an “isolated” or “purified” nucleic acid molecule, polynucleotide, polypeptide, protein or organic compound, such as a small moleculeis substantially free of other compounds, such as cellular material, with which it is associated in nature.
- a purified or isolated polynucleotideribonucleic acid (RNA) or deoxyribonucleic acid (DNA)
- RNAribonucleic acid
- DNAdeoxyribonucleic acid
- a purified or isolated polypeptideis free of other molecules, or the amino acids that flank it, in its naturally-occurring state.
- an isolated microbe strainmeans that the strain is removed from the environment in which it exists in nature.
- the isolated strainmay exist as, for example, a biologically pure culture, or as spores (or other forms of the strain) in association with a carrier.
- purified compoundsare at least 60% by weight the compound of interest.
- the preparationis at least 75%, more preferably at least 90%, and most preferably at least 99%, by weight the compound of interest.
- a purified compoundis one that is at least 90%, 91%, 92%, 93%, 94%, 95%, 98%, 99%, or 100% (w/w) of the desired compound by weight. Purity is measured by any appropriate standard method, for example, by column chromatography, thin layer chromatography, or high-performance liquid chromatography (HPLC) analysis.
- HPLChigh-performance liquid chromatography
- Ranges provided hereinare understood to be shorthand for all of the values within the range.
- a range of 1 to 20is understood to include any number, combination of numbers, or sub-range from the group consisting 1, 2, 3, 4, 5, 6, 7, 8, 9, 10, 11, 12, 13, 14, 15, 16, 17, 18, 19 and 20, as well as all intervening decimal values between the aforementioned integers such as, for example, 1.1, 1.2, 1.3, 1.4, 1.5, 1.6, 1.7, 1.8, and 1.9.
- “nested sub-ranges”that extend from either end point of the range are specifically contemplated.
- a nested sub-range of an exemplary range of 1 to 50may comprise 1 to 10, 1 to 20, 1 to 30, and 1 to 40 in one direction, or 50 to 40, 50 to 30, 50 to 20, and 50 to 10 in the other direction.
- reducesmeans a negative alteration of at least 1%, 5%, 10%, 20%, 30%, 40%, 50%, 60%, 70%, 80%, 90%, or 100%.
- a “metabolite”refers to any substance produced by metabolism (e.g., a growth by-product) or a substance necessary for taking part in a particular metabolic process.
- metabolitesinclude, but are not limited to, enzymes, acids, solvents, gases, alcohols, proteins, vitamins, minerals, microelements, amino acids, biopolymers, and biosurfactants.
- surfactantmeans a surface-active compound that lowers the surface tension (or interfacial tension) between two liquids or between a liquid and a solid.
- Surfactantscan act as, e.g., detergents, wetting agents, emulsifiers, foaming agents, and/or dispersants.
- a “biosurfactant”is a surfactant produced by a living cell.
- transitional term “comprising,” which is synonymous with “including,” or “containing,”is inclusive or open-ended and does not exclude additional, unrecited elements or method steps.
- the transitional phrase “consisting of”excludes any element, step, or ingredient not specified in the claim.
- the transitional phrase “consisting essentially of”limits the scope of a claim to the specified materials or steps “and those that do not materially affect the basic and novel characteristic(s)” of the claimed invention.
- Use of the term “comprising”contemplates other embodiments that “consist” or “consist essentially of” the recited component(s).
- the term “about”is understood as within a range of normal tolerance in the art, for example within 2 standard deviations of the mean. About can be understood as within 10%, 9%, 8%, 7%. 6%, 5%, 4%, 3%, 2%, 1%, 0.5%, 0.1%, 0.05%, or 0.01% of the stated value.
- the subject inventionprovides a composition for improving oil and/or gas production, the composition comprising one or more solvents and one or more surfactants.
- the compositioncomprising one or more solvents and one or more surfactants.
- any combination of solventsis utilized with any combination of surfactants.
- the compositioncomprises one or more yeast fermentation products, one or more surfactants, one or more solvents, and one or more chelating agents.
- one or more ammonium salts and/or co-surfactantscan also be included.
- the compositionis customized based on the type of paraffin that is being treated.
- paraffin depositscan vary from soft accumulations to hard, brittle, solidified deposits.
- the concentration of solvent in the compositioncan be increased (e.g., up to about 10% of the composition) to boost the dispersal capabilities when harder paraffins are present.
- the practice of the subject inventioncomprises obtaining an analyzing a sample of paraffin from the site to be treated.
- compositionsis shelf stable for at least one week or longer, and can be transported, stored and then applied selectively to an oil well at any point, for example, after a decline in oil and/or gas production is observed.
- the solvent(s) and/or the surfactant(s)can be produced by non-biological means (e.g., chemical isolation, purification and/or synthesis).
- the solvents and/or surfactantscan be derived from natural or biological sources, such as, for example, the living cells of microorganisms, plants, fungi and/or animals.
- the compositioncomprises a first yeast fermentation product that comprises a yeast strain and/or by-products produced during cultivation of the yeast.
- the microbeis a yeast or fungus, such as, for example, Wickerhamomyces anomalus ( Pichia anomala ), Starmerella bombicola or Meyerozyma guilliermondii ( Pichia guilliermondii ).
- the yeastsare inactivated, for example, using thermal inactivation, prior to being added to the subject composition.
- yeast fermentation products according to the subject inventioncan be superior to, for example, purified microbial metabolites alone, due to, for example, the advantageous properties of the yeast cell walls.
- These propertiesinclude high concentrations of mannoprotein as a part of yeast cell wall's outer surface (mannoprotein is a highly effective bioemulsifier) and the presence of biopolymer beta-glucan (also an effective emulsifier) in yeast cell walls.
- the yeast fermentation productfurther can comprise biosurfactants capable of reducing both surface and interfacial tension, enzymes capable of solubilizing heavy hydrocarbon and/or paraffinic compounds, and other metabolites (e.g., lactic acid, ethyl acetate, ethanol, etc.), in the culture.
- certain fungiother than yeasts, have cell walls containing the same advantageous properties. Accordingly, fermentation products comprising non-yeast fungi can also be used according to the subject invention.
- a first yeast fermentation productdesignated as “Star 3+,” can be obtained via cultivation of a yeast, e.g., Wickerhamomyces anomalus , using a modified form of solid state fermentation.
- the culturecan be grown on a substrate with ample surface area onto which the yeasts can attach and propagate, such as, for example, corn flour, rice, soybeans, chickpeas, pasta, oatmeal or beans.
- the culturecan be washed out and used in liquid form, or blended with the solid substrate, milled and/or micronized, and optionally, dried. This comprises the Star 3+ product.
- the productcan be diluted in water and/or brine fluids, for example, at least 5, 10, 100, 500 or 1,000 times prior to being added to the composition.
- the first yeast fermentation productis obtained using submerged fermentation, wherein the first yeast fermentation product comprises liquid broth and, optionally, cells and any yeast growth by-products resulting from the submerged fermentation.
- composition according to the subject inventioncan comprise one or more solvents to aide in, for example, dissolving and dispersing paraffins.
- a combination of solventsis utilized.
- the compositioncomprises solvents at a concentration of about 50% or less, 25% or less, or 10% or less, by volume.
- the one or more solventsare not produced by the yeasts of the yeast fermentation product, meaning they are included in addition to any solvents that may be produced by the yeast of the first yeast fermentation product.
- the one or more solventsare non-polar aromatic solvents.
- the solventscan include one or more of, for example, terpenes, terpenoids, acetates, ionic or semi-ionic liquids, alcohols, kerosene, gasoline, diesel, benzene, toluene, and/or xylene.
- the solventscan comprise one or more acetates.
- the acetatesare naturally-derived.
- the acetatesinclude isoamyl acetate and/or primary amyl acetate.
- the acetate(s)can be included at a concentration of about 10 ml/L to 200 ml/L, about 20 ml/L to 175 ml/L, about 30 ml/L to 150 ml/l, about 40 ml/L to 125 ml/L, or about 50 ml/L to 100 ml/L.
- the solventscan comprise one or more terpenes and/or terpenoids.
- the terpenes or terpenoidsare derived from plants, such as citrus plants or pine trees.
- Terpenes and terpenoidscan include but are not limited to, limonenes, orange terpenes, lemon terpenes, grapefruit terpenes, orange oil, lemon oil, other citrus terpenes, other citrus oils, geraniol, terpineol, dipentene, myrcene, linalool, cymene and pinene.
- the terpenes and/or terpenoidsinclude turpentine, D-limonene and/or dipentene at a concentration of about 1.0% to about 10.0% by weight, or about 2.0% to about 8.0% by weight.
- the concentration of turpentine, D-limonene and/or dipenteneis about 10 ml/L to 200 ml/L, about 20 ml/L to 175 ml/L, about 30 ml/L to 150 ml/l, about 40 ml/L to 125 ml/L, or about 50 ml/L to 100 ml/L.
- the solventscan comprise one or more alcohols, such as, for example, ethanol, methanol, propanol, isopropyl alcohol and/or hexanol.
- the compositioncomprises hexanol and/or isopropyl alcohol, at a concentration of about 1 ml/L to 200 ml/L, about 2 ml/L to 175 ml/L, about 3 ml/L to 150 ml/l, or about 4 ml/L to 100 ml/L.
- the solventscan comprise one or more ionic or semi-ionic liquids.
- exemplary ionic or semi-ionic liquids suitable for the subject compositioninclude, but are not limited to, ethyl ammonium nitrate, and/or a semi-ionic mixture of glycerin/glycerol with magnesium sulfate heptahydrate (MgSO 4 .7H 2 O).
- the mixture of glycerol and Epsom salt (MgSO 4 .7H 2 O)has a ratio of glycerol to Epsom salt of 1:1 to 1:10, or from 1:1 to 10:1.
- the ionic or semi-ionic liquidcan act as a co-solvent and can prevent the formation of ring bonds in hydrocarbon compositions, which is one cause of hydrocarbon precipitation.
- the ionic or semi-ionic liquidis present in the composition at a concentration of about 10 ml/L to 200 ml/L, about 20 ml/L to 175 ml/L, about 30 ml/L to 150 ml/l, about 40 ml/L to 125 ml/L, or about 50 ml/L to 100 ml/L.
- the compositioncomprises one or more surfactants, which, along with paraffin removal and/or dispersal, can provide additional enhanced oil recovery due to, for example, their surface and interfacial tension reduction properties.
- the surfactant(s)can be of non-biological origin and/or they can be biosurfactants, meaning surfactants produced by a living cell.
- Non-biological surfactantscan be selected from, for example, anionic, cationic, zwitterionic and/or nonionic classes of surfactants.
- the surfactantsare microbial biosurfactants or a blend of more than one type of biosurfactant.
- Biosurfactantsare a structurally diverse group of surface-active substances produced by microorganisms. Biosurfactants are biodegradable and can produced using selected organisms in or on renewable substrates.
- biosurfactantsare amphiphiles. They consist of two parts: a polar (hydrophilic) moiety and non-polar (hydrophobic) group. Due to their amphiphilic structure, biosurfactants increase the surface area of hydrophobic water-insoluble substances, increase the water bioavailability of such substances, and change the properties of bacterial cell surfaces. Furthermore, biosurfactants accumulate at interfaces, and reduce the surface and interfacial tension between the molecules of liquids, solids, and gases, thus leading to the formation of aggregated micellar structures in solution.
- Biosurfactants according to the subject inventioninclude, for example, low-molecular-weight glycolipids, lipopeptides, fatty acid ester compounds, fatty acid ether compounds, flavolipids, phospholipids, and high-molecular-weight polymers/biopolymers such as lipoproteins, lipopolysaccharide-protein complexes, and/or polysaccharide-protein-fatty acid complexes.
- the biosurfactantsare produced by microorganisms
- the biosurfactantscan comprise one or more glycolipids such as, for example, rhamnolipids, rhamnose-d-phospholipids, trehalose lipids, trehalose dimycolates, trehalose monomycolates, mannosylerythritol lipids, cellobiose lipids, ustilagic acid and/or sophorolipids (including lactonic and/or acidic forms).
- glycolipidssuch as, for example, rhamnolipids, rhamnose-d-phospholipids, trehalose lipids, trehalose dimycolates, trehalose monomycolates, mannosylerythritol lipids, cellobiose lipids, ustilagic acid and/or sophorolipids (including lactonic and/or acidic forms).
- the surfactantis a mannosylerythritol lipid (MEL), comprising either 4-O—B-D-mannopyranosyl-meso-erythritol or 1-O—B-D-mannopyranosyl-meso-erythritol as the hydrophilic moiety, and fatty acid groups and/or acetyl groups as the hydrophobic moiety.
- MELmannosylerythritol lipid
- One or two of the hydroxylstypically at the C4 and/or C6 of the mannose residue, can be acetylated.
- there can be one to three esterified fatty acidsfrom 8 to 12 carbons or more in chain length.
- MEL moleculescan be modified, either synthetically or in nature.
- MELcan comprise different carbon-length chains or different numbers of acetyl and/or fatty acid groups.
- MEL molecules and/or modified forms thereof according to the subject inventioncan include, for example, tri-acylated, di-acylated, mono-acylated, tri-acetylated, di-acetylated, mono-acetylated and non-acetylated MEL, as well as stereoisomers and/or constitutional isomers thereof.
- the MEL moleculesare selected from members of the following groups: MEL A (di-acetylated), MEL B (mono-acetylated at C4), MEL C (mono-acetylated at C6), MEL D (non-acetylated), tri-acetylated MEL A, tri-acetylated MEL B/C, and further including all possible isomers of the members of these groups.
- MEL-like moleculesthat exhibit similar structures and similar properties, can also be produced according to the subject invention, e.g., mannosyl-mannitol lipids (MML), mannosyl-arabitol lipids (MAL), and/or mannosyl-ribitol lipids (MRL).
- MMLmannosyl-mannitol lipids
- MALmannosyl-arabitol lipids
- MRLmannosyl-ribitol lipids
- the biosurfactantscan comprise one or more lipopeptides, such as, for example, surfactin, iturin, fengycin, arthrofactin, viscosin, amphisin, syringomycin, and/or lichenysin.
- lipopeptidessuch as, for example, surfactin, iturin, fengycin, arthrofactin, viscosin, amphisin, syringomycin, and/or lichenysin.
- the biosurfactantscan comprise one or more other types of biosurfactants, such as, for example, cardiolipin, emulsan, lipomanan, alasan, and/or liposan.
- the surfactantscan comprise one or more microbial-produced fatty acid ester compounds having physical properties and/or behaviors similar to those of biosurfactants, but which are not commonly known as biosurfactants.
- the fatty acid ester compoundscan be represented by the following formula:
- the fatty acid ester compoundscan include, for example, highly esterified oleic fatty acids, such as oleic fatty acid ethyl esters and/or oleic fatty acid methyl esters (FAME).
- highly esterified oleic fatty acidssuch as oleic fatty acid ethyl esters and/or oleic fatty acid methyl esters (FAME).
- the surfactantscan comprise one or more microbial-produced fatty acid ether compounds having physical properties and/or behaviors similar to those of biosurfactants, but which are not commonly known as biosurfactants.
- the fatty acid ether compoundscan be represented by the following formula:
- R 1C 6 to C 22 saturated or unsaturated hydrocarbon, or an epoxide, or cyclopropane thereof
- the biosurfactantscan be added to the composition in a crude and/or purified form.
- the concentration of biosurfactantis about 10 ml/L to 200 ml/L, about 25 ml/L to 175 ml/L, about 30 ml/L to 150 ml/l, about 40 ml/L to 125 ml/L, or about 50 ml/L to 100 ml/L.
- the surfactant concentrationis no lower than critical micelle concentration (CMC) at the time the composition is introduced into the formation (e.g., after natural dilution occurs within the formation).
- CMCcritical micelle concentration
- the biosurfactantscan be present as a growth by-product of a cultivated yeast, although preferably, they are included in addition to any biosurfactants that may happen to be present as growth by-products in the first yeast fermentation product.
- the biosurfactantcan be added to the composition in the form of a microbial culture, e.g., a second yeast fermentation product, containing liquid fermentation broth and cells resulting from submerged cultivation of a biosurfactant-producing microbe, e.g., Wickerhamomyces anomalus, Starmerella bombicola or Meyerozyma guilliermondii .
- a biosurfactant-producing microbee.g., Wickerhamomyces anomalus, Starmerella bombicola or Meyerozyma guilliermondii .
- the second yeast fermentationis not produced using the same yeast as the first yeast fermentation product.
- a second yeast fermentation productcomprising fermentation broth with Starmerella bombicola yeast cells and SLP therein, can be added to the composition.
- the fermentation broth after, for example, 5 days of cultivation at 25° C.can contain the yeast cell suspension and, for example, 150 g/L or more of SLP.
- the yeast cellsmay be active or inactive at the time they are added to the composition.
- the SLP portions of the culturewhich forms a distinct layer in the culture, can be removed, and the residual liquid having, for example, 1-4 g/L residual SLP and, optionally, yeast cells and other growth by-products, can be utilized in the subject composition.
- the residual liquidhaving, for example, 1-4 g/L residual SLP and, optionally, yeast cells and other growth by-products, can be utilized in the subject composition.
- a similar productis envisioned that utilizes any other microbe capable of producing the other biosurfactant.
- the amount of the second yeast fermentation product in the compositionis about 15 to 25% of the total composition by volume, preferably about 20% of total volume.
- the surfactants of the compositionsare obtained through cultivation of microorganisms using processes ranging from small to large scale.
- the cultivation processcan be, for example, submerged cultivation, solid state fermentation (SSF), and/or a combination thereof.
- the compositionfurther comprises one or more chelating agents.
- chelatoror “chelating agent” means an active agent capable of removing a metal ion from a system by forming a complex so that the metal ion, for example, cannot readily participate in or catalyze oxygen radical formation.
- chelating agents suitable for the present inventioninclude, but are not limited to, dimercaptosuccinic acid (DMSA), 2,3-dimercaptopropanesulfonic acid (DMPS), alpha lipoic acid (ALA), thiamine tetrahydrofurfuryl disulfide (TTFD), penicillamine, ethylenediaminetetraacetic acid (EDTA), sodium acetate, sodium citrate and citric acid.
- DMSAdimercaptosuccinic acid
- DMPS2,3-dimercaptopropanesulfonic acid
- ALAalpha lipoic acid
- TTFDthiamine tetrahydrofurfuryl disulfide
- penicillamineethylenediaminetetraacetic acid
- sodium acetatesodium citrate and citric acid.
- the chelating agentis selected from EDTA, citric acid, citrate, sodium acetate, or a mixture thereof.
- the chelating agent or mixture thereofcan be added to the composition in concentrations of about 1 g/L to about 50 g/L, or about 5 g/L to about 25 g/L, or about 10 g/L to about 15 g/L.
- the chelating agentis sodium citrate.
- the subject compositioncan further comprise carriers (e.g., water, oil and/or brine fluids), as well as other optional compounds that are useful for paraffin removal and/or enhanced oil recovery, such as, for example, ammonium salts, co-surfactants, and/or enzymes.
- carrierse.g., water, oil and/or brine fluids
- other optional compoundsthat are useful for paraffin removal and/or enhanced oil recovery, such as, for example, ammonium salts, co-surfactants, and/or enzymes.
- additional compoundscan be added at concentrations ranging from, for example, about 0.001% to 50%, about 1% to 25%, or about 10%, by weight or volume.
- the compositionoptionally comprises one or more ammonium salts, for example, ammonium hydroxide, ammonium phosphate, monoammonium phosphate, diammonium phosphate, ammonium chloride, or another dibasic or monobasic ammonium salt.
- ammonium saltscan serve pH adjusters in the composition, balancing the pH of the composition towards, or at, a neutral pH (e.g., about pH 6 to 8) even in the presence of acidic substances, such as brine fluids. This can be useful for improving the acid number of crude oil recovered from the treated formation, as well as for preventing the corrosion of equipment due to contact with acidic substances.
- the ammonium salt(s)comprise ammonium hydroxide (e.g., a 70% solution) at a concentration of about 1 ml/L to 10 ml/L, or about 2 ml/L to 8 ml/L, or about 3 ml/L to 5 ml/L; and/or monoammonium phosphate, at a concentration of about 1 g/L to 50 g/L, or about 2 g/L to about 30 g/L, or about 10 g/L to about 20 g/L.
- ammonium hydroxidee.g., a 70% solution
- the compositionoptionally comprises one or more co-surfactants.
- the co-surfactantis monoammonium phosphate or a surfactant as described previously herein, e.g., a MEL or an esterified fatty acid.
- the compositioncomprises one or more yeast fermentation products, one or more surfactants, one or more solvents, one or more chelating agent(s), and, optionally, one or more ammonium salts and/or co-surfactants.
- the one or more yeast fermentation productscomprise Star 3+.
- the one or more surfactantscomprise MEL, an esterified fatty acid, and/or SLP.
- the one or more solventscomprise isopropyl alcohol, isoamyl acetate, primary amyl acetate, turpentine, dipentene and/or D-limonene.
- the one or more chelating agentscomprise sodium citrate.
- the optional one or more ammonium saltscomprise ammonium hydroxide and/or monoammonium phosphate.
- monoammonium phosphatecan also serve as a co-surfactant.
- the compositioncan be diluted using water, oil, or any other diluent, including, for example, sterilized produced water from an oil well.
- compositions of the subject inventionprovide a wide range of benefits to the oil and gas industry, including at all stages of production.
- the subject compositionscan be used as cleaning agents to remove and liquefy paraffin deposits; paraffin dispersants; emulsifiers; viscosity reducers; EOR agents; paraffin inhibitors; antibacterial agents; corrosion inhibitors; and other uses, as are described throughout this description.
- compositionscan be formulated to be particularly potent for use in liquefying long-chain paraffins, which can be particularly difficult to dissolve;
- the subject inventionprovides materials and methods for improving oil and/or gas production from a well and/or a subterranean formation.
- the subject inventioncan be used to remove paraffins and other contaminants from wells, wellbores, subterranean formations and production equipment associated with wells, wellbores, and formations, that might, for example, obstruct or slow the flow of oil and/or gas.
- the subject methodcan enhance oil recovery from an oil well or formation.
- the subject methodscan be used in, for example, vertical, horizontal and/or fracking wells, mature wells, stripper (marginal) wells, flowlines, as well as to clean and/or maintain wellbores, piping, tubing, storage tanks, and other equipment.
- use of the subject inventioncan improve and/or enhance oil recovery, aid in well stimulation, and restore the health (e.g., production capacity) of under-producing or even dead wells.
- the subject inventionprovides methods of improving oil and/or gas production, wherein a composition according to the subject invention is applied to a subterranean formation, an oil and/or gas well, a wellbore, and/or equipment associated therewith.
- the methodscan also enhance oil recovery from the oil well.
- the methodsare implemented once the rate of oil production from a well has begun to decline due to, for example, obstructing contaminants.
- the methodsare effective at dissolving paraffinic buildup without need for mechanical cleaning solutions.
- the methodsobviate the need for toxic solvents.
- the methodscan utilize compositions that are customized for a particular well.
- the methodcomprises testing the well and/or associated equipment, analyzing the paraffin composition present therein and determining the preferred formulation for the composition prior to treatment.
- the subject methodscan be useful for removal and dispersal of a broad spectrum of paraffin types, including shorter chain paraffins as well as longer chain paraffins that are particularly difficult to remove due to, for example, the heaviness, thickness and/or the hardness of the deposit.
- the methodsimprove oil and/or natural gas production through the removal and dispersal of paraffin deposits and/or precipitates that have accumulated in a subterranean formation, in an oil and/or gas well, in a wellbore and/or in production equipment associated with any of these.
- the methodsare useful for removing paraffin deposits from the rock pores of subterranean formations, from wells, wellbores, and from equipment, such as, for example, tubing, pipes, drills and tanks associated with all aspects of oil and/or gas production.
- the subject compositions and methodscan also free stuck or floating rods, allowing inoperable wells to resume operation. The methods can also be useful in treating mature wells and wells that have undergone hot oiling.
- the methodsprovide for recovery of economically valuable paraffin hydrocarbons by dispersing and/or emulsifying the dislodged paraffin back into crude oil fluids.
- applying the subject compositionhelps inhibit paraffin crystallization and deposition, and helps prevent re-crystallization and re-deposition of dispersed paraffins while pumping and transporting.
- the methodsare even effective at keeping the paraffins suspended/emulsified in the crude oil fluids at temperatures less than 90° C., less than 50° C., less than 25° C., and even less than 0° C., for example from ⁇ 3° C. to ⁇ 32° C.
- the methodsalso enhance oil recovery through, for example, the amphiphilic properties of surfactants, including biosurfactants.
- the subject methodscan also be useful for a multitude of other benefits related to oil and gas recovery, including, for example: inhibition of paraffin crystallization and prevention of paraffin deposition; reduction in viscosity of paraffinic crude oil: reduction in pour point of paraffinic crude oil (e.g., to about ⁇ 25° F./ ⁇ 32° C.); removal and/or dissolution of scale; release of rust from oilfield casings and related equipment; protection against under-deposit rust-related corrosion of equipment; inhibition of bacterial growth and disruption of biofilm formation on equipment; protection against microbial induced corrosion (MIC); alteration of the wettability of the near-wellbore surface to water-wet; and remediation of formation skin damage.
- MICmicrobial induced corrosion
- applyingrefers to contacting it with a target or site such that the composition or product can have an effect on that target or site.
- the effectcan be due to, for example, the individual ingredients of the subject compositions and/or a synergistic combination thereof.
- the methodmay be implemented using a composition according to the subject invention, for example, the compositions can be injected into oil wells and/or the piping, tubulars, casing, annulus, pumps, and tanks associated with oil-bearing formations, oil wells, oil production, oil transmission and oil transportation.
- Application of the compositioncan be performed during drilling operations (e.g., while drilling, while tripping-in or tripping-out of the hole, while circulating mud, while casing, while placing a production liner, and/or while cementing, etc.). Application can also occur as a production treatment, for example, by introducing the composition into an oil well after oil production is underway and/or after a decline in the rate of oil production from the formation has occurred.
- the volume of treatment usedcan be determined taking into account, for example, formation porosity, permeability and deposit thickness.
- the treatmentcan produce effects in less than 24 hours of shut-in time.
- a composition of the subject inventionis poured or injected down the casing side (back lines) of a well and allowing it to mix with the fluid that is already in the well.
- the compositioncan then optionally be circulated by, for example, a pump for 24-72 hours, preferably 48-72 hours. Prior to circulating, the composition may be allowed to set for 8 to 24 hours, for example.
- the setting time, circulating time and dosagedepend on the amount of paraffin and/or other contaminants anticipated to be present, as well as the depth and size of the well.
- a basic initial dosagecan be, but is not limited to, 20 gallons of composition and for maintaining a clear structure, at least about 5 gallons of composition per well on periodic basis, e.g. biweekly, monthly, bimonthly.
- the methodscomprise pumping, for example, 100 to 1,000 gallons of more of the composition into and out of an oil well. Injection rates can be determined by a skilled oil well operation, although, as an example, an injection rate of 1 to 20 gallons per minute, or 1 to 20 barrels per minute can be used in some embodiments.
- the methodscomprise applying between about 100-1,000 gallons, or 200 to 600 gallons of the composition into the annulus between the tubing and casing, where it can flow through the pump and into the tubing.
- the compositioncan be introduced into the formation through perforations in the casing.
- the compositionmay be forced into the surrounding formation by applied pressure or, if the composition is allowed to set at the bottom of the casing, the composition may seep into the formation without additional pressure.
- the compositionpermeates the formation, improving the rate of oil recovery by a number of mechanisms such as, for example, dissolving paraffin and other contaminant blockages in the formation pore throats.
- the compositionmay be introduced by means of injection pumps into off-shore gas or oil wells to reduce contaminants in well casings and transmission lines.
- the lines and contents between the bottom of the ocean and the platform associated with off-shore wellsare cooled by the ocean or sea water, thus increasing the crystallization and deposition rate of scale, paraffin and asphaltene.
- To treat the linesfrom 1-500 gallons up to 1000 barrels, 10,000 barrels, or more, for example, of the composition can be introduced therein.
- brine fluidscan be injected into a well after the subject compositions in order to push the treatment deeper into the formation.
- the subject treatmentcan be effective in a range of different geologic formations.
- the subject inventioncan be useful in formations as deep as about 7,000 feet or deeper, and as shallow as about 1,500 feet or shallower.
- the inventioncan be useful in formations having a range of porosity and/or permeability, for example from about 0.1% to about 20% or more.
- the inventioncan also be useful in formations having a wide range of temperatures, pH, and salinity.
- the subject methodscan replace methods that utilize synthetic or chemical paraffin inhibiters for preventing crystallization, precipitation and/or deposition of paraffin. Furthermore, the subject methods can reduce or replace the need for physical alteration of equipment to prevent paraffin crystallization and deposition.
- the subject inventioncan be used to improve one or more qualities of crude oil.
- the methodscan be used to reduce the viscosity of paraffinic crude oil, thus allowing for more efficient recovery of the oil from a well.
- improving one or more qualities of crude oilcomprises altering the pour point and/or cloud point of paraffinic crude oil, for example, by lowering the pour point and/or cloud point.
- Reduction in cloud point and/or pour pointallows for the methods and composition of the subject invention to be utilized in lower temperatures, for example, with offshore oil wells, in formations and equipment present or being transported in colder climates, and/or during the winter. This is because, in the case of pour point, the temperature at which the oil crystallizes and/or freezes is lower, and in the case of cloud point, the temperature at which the dissolved solids and paraffins in the oil precipitate is lower.
- the subject inventioncan be used to prevent re-deposition of paraffins while pumping and transport, even in colder temperatures.
- the subject inventioncan lower the pour point of paraffinic crude oil to about ⁇ 25° F., or to about ⁇ 32° C.
- the subject methodscan be used to remove and/or dissolve scale present in a formation and/or on equipment.
- These problematic depositscan be formed by, for example, deposits of precipitated mineral salts, which can arise as a result of, for example, changes in the pressure, composition and/or temperature of the crude oil.
- Scalescan result from precipitates of, for example, barium sulfate, calcium carbonate, strontium sulfate, calcium sulfate, sodium chloride, silicon dioxide, iron sulfide, iron oxides, iron carbonate, silicates, phosphates and oxides, or any of a number of compounds that are insoluble or mildly soluble in water.
- the methods of the subject inventioncan be used for preventing corrosion associated with rust deposits, which can develop underneath paraffin deposits.
- the compositions and methodscan also help release other rust deposits from oilfield casings and other related equipment.
- the methodscan be used to inhibit bacterial growth within an oil well or associated equipment, including inhibiting biofilm formation and/or disrupting biofilms present on the surfaces of equipment.
- the inventioncan be useful against Gram-negative and Gram-positive bacteria, such as chemoautotrophic bacteria, sulfate-reducing bacteria, sulfuric acid-producing bacteria, iron-oxidizing bacteria, and/or acid or ammonia-producing bacteria, and can help protect oil and gas production equipment from MIC.
- the methodscan open up channels and pores that are clogged with paraffin deposits, as well as with the adhesive/cohesive matrices that form when scale, polymers, sand, and other materials become lodged in the paraffin, thus allowing for improved formation permeability and oil production.
- the subject methodscan also alter the wettability of formation rock so that it is water-wet. Thus, the subject methods can be used to remediate formation “skin damage.”
- Skin damageis an occurrence characterized by a zone of reduced permeability within the vicinity of the wellbore.
- the reduction in permeabilitycan be a result of, for example, deposits, such as paraffins, asphaltenes, and bacterial biofilms, as well as alterations in the wettability of formation rock from water-wet to oil-wet due to, for example, contaminating deposits, oil-based drilling fluids, and the use of BTEX solvents.
- the subject treatmentcan be effective in a range of different geologic formations.
- the subject inventioncan be useful in formations as deep as about 7,000 feet or deeper, and as shallow as about 1,500 feet or shallower.
- the inventioncan be useful in formations having ranges of porosity and/or permeability, for example from about 0.1% to about 20% or more.
- the inventioncan also be useful in formations having a wide range of temperatures, pH, and salinity.
- the subject inventioncan be utilized in recovery and transport of oil in locations where lower temperatures might cause paraffin deposition, such as, for example, in offshore wells, in the arctic or Antarctic, and in climates that experience cold winter temperatures.
- the subject inventioncan be utilized in oil wells with high formation water salinity levels.
- the compositionscan be useful in geologic regions where formation water salinity is up to 250,000 ppm (total dissolved solids), up to 300,000 ppm, or even up to 400,000 ppm or more.
- the methodscan also be used for maintenance of equipment, for example, pipes, tubulars, drills, pumps, casings, tanks, rods, boreholes, and other structures and equipment involved in oil and/or gas production and processing.
- the compositionmay be applied directly to equipment. For example, prior to placing rods and casings into gas and/or oil wells, these parts may be sprayed with, or soaked in, the composition. The parts may be dipped into tanks filled with the composition to prevent under-deposit corrosion and buildup of contaminants.
- any equipment or component of oil production, processing, transportation, storage and/or refiningcan be treated and maintained with a composition of the subject invention.
- the subject inventioncan be applied to equipment involved in all stages of the chain of operations, including exploration and production (E&P) (e.g., onshore and offshore wellbores, flowlines, and tanks), midstream (e.g., pipelines, tankers, transportation, storage tanks), and in refineries (e.g., heat exchangers, furnaces, distillation towers, cokers, hydrocrackers).
- E&Pexploration and production
- midstreame.g., pipelines, tankers, transportation, storage tanks
- refineriese.g., heat exchangers, furnaces, distillation towers, cokers, hydrocrackers.
- maintenance of equipmentis achieved through the prevention, removal, and/or dispersal of contaminating deposits that form on the equipment.
- contaminants associated with oil production equipmentsuch as paraffins, scales, oils, asphalts/asphaltenes, resins, sulfur, tar by-products, biofilms, and other viscous materials.
- the composition of the present inventioncan be used to remove any one or more of the contaminants associated with oil recovery, transmission and processing.
- the contaminantis paraffin.
- the subject inventioncan be used for preventing precipitation and/or deposition of contaminants from occurring.
- the present inventionallows for delaying or completely removing the necessity for preventative maintenance related to removing precipitates and deposits, as well as the need for replacing or repairing equipment parts.
- the subject compositioncan further be applied for dissolving and dispersal of contaminant buildup in, for example, storage and transportation tanks, tankers, ships, trucks, pipelines and flowlines, without need for mechanical cleaning solutions or toxic solvents.
- methods of cleaning a storage or transportation tankwherein air or methane is injected under pressure into a tank. This can either be preceded by or followed by injection of the subject composition. Waste water is pumped to a treatment plant after treatment with the subject composition. Preferably, the air or methane is injected into the tank to allow for approximately 10 minutes of roiling.
- the compositionmay be applied with a substance that promotes adherence of composition to a surface to be treated.
- the adherence-promoting substancemay be a component of composition or it may be applied simultaneously with, or sequentially with, the composition.
- Adherence-promoterscan include organic or inorganic particles, ions such as calcium, magnesium, phosphate, and sodium, iron, carbon sources that are metabolized to acetyl coenzyme A, acetyl phosphate, and acetate.
- additivesUp to, for example, 50 wt. % or more of further additives may be applied, as needed, for particular applications, such as to vary the VOC levels, increase penetration of the composition, decrease viscosity of the composition, and/or as couplers for solvent insolubles in the mixture.
- Suitable additivesinclude, but are not limited to, C8-C14 alcohol ester blends, glycols, glycol ethers, acid esters, diacid esters, petroleum hydrocarbons, amino acids, alkanolamines, amines, methyl or isobutyl esters of C4-C6 aliphatic dibasic esters and n-methyl-2 pyrolidone.
- C8-C14 alcohol ester blendsinclude EXXATE 900, 1000, 1200 from Exxon Chemical; glycols include propylene glycol, dipropylene glycol, and triproplylene glycol; and glycol ethers include dipropylene glycol monomethyl ether, propylene glycol monomethyl ether, propylene glycol-n-butyl ether, ethylene glycol monobutyl ether, and diethylene glycol monobutyl ether.
- Acid estersinclude methyl oleate and methyl linoleate, and diacid esters include methyl or butyl diesters of glutaric, adipic, and succinic acids.
- Petroleum hydrocarbonsinclude AROMATIC 100, AROMATIC 150 ISOPAR M, and ISOPAR K.
- Aminessuch as morpholine; 1,3-dimethyl-2-imidazolidinone; 1, 3-propanediamine; 2-amino-1,3-propanediol; and 3-amino propanol; as well as alkanolamines such as triethanolamine, diethanolamine, 2-aminomethyl propanol, and monoethanolamine act as dispersants for contaminants and solubilize fatty acids and oils.
- Amino acidsprovide nontoxic alternatives to monoethanolamine, and act as metal chelators. Methyl or isobutylesters of C4-C6 aliphatic dibasic esters and n-methyl-2 pyrolidone are also useful.
- water softening agentsinclude linear phosphates, styrene-maleic acid co-polymers, and polyacrylates.
- Suitable sequesterantsinclude 1,3-dimethyl-2-immidazolidinone; 1-phenyl-3-isoheptyl-1,3-propanedione; and 2 hydroxy-5-nonylacetophenoneoxime.
- corrosion inhibitorsinclude 2-aminomethyl propanol, diethylethanolamine benzotraizole, and methyl benzotriazole.
- Antioxidants suitable for the present inventioninclude (BHT) 2,6-di-tert-butyl-para-cresol, (BHA) 2,6-di-tert-butyl-para-anisole, Eastman inhibitor O A BM-oxalyl bis (benzylidenehydrazide), and Eastman DTBMA 2,5-di-tert-butylhydroquinone.
- All additivesshould have a flash point greater than 100° F., preferably greater than 150° F. and more preferably 195° F. TCC in order to achieve a final product flash point greater than 200° F.
- the subject methodscan be used alongside and/or to enhance or supplement other methods of paraffin removal and/or enhanced oil recovery, e.g., other microbial, mechanical, thermal and/or chemical treatments.
- the methodcan be used to replace dangerous high heat steaming or oiling methods commonly used for paraffin removal.
- thermal, steaming and/or hot oil methodsare used, the present method can be used alongside (before, during or after) the thermal, steaming and/or hot oil to prevent recrystallization of the liquefied paraffins that are dispersed in the oil.
- the subject methodscomprise a chemical treatment for removing paraffin deposits present, for example, at or near a wellbore.
- the chemical treatment methodcan comprise applying a composition that comprises one or more chemical solvents and one or more non-biological surfactants to the wellbore.
- the combination of solvents with surfactantswhen compared to using, for example, solvents alone, can also provide enhanced oil recovery in addition to effectively dispersing paraffin back into crude oil fluids.
- this chemical treatmentdoes not require large volumes of treatment mixture, as is required for treating deep into a subterranean formation.
- the surfactantscan comprise, for example, from 1% to 50% of the volume of the chemical treatment composition, from 2% to 20%, or from 5% to 10%.
- compositions and methodscan be used before and/or after administration of a mechanical, thermal and/or chemical treatment, and/or simultaneously therewith. Furthermore, the subject compositions and methods can simply comprise a mechanical, thermal and/or chemical treatment on its own.
- Examples of mechanical treatmentsinclude, but are not limited to, scraping, cutting and/or knifing, soluble pigs (made of, e.g., naphthalene or microcrystalline wax) or insoluble pigs (made of, e.g., plastic or hard rubber).
- Mechanical prevention of paraffin depositioncan include the use of plastic or coated pipes, or other low-friction, smooth surfaces on equipment.
- thermal treatmentsinclude, but are not limited to, steaming, hot watering and/or hot oiling.
- Examples of chemical paraffin treatmentsinclude, but are not limited to, non-biological (e.g., produced by chemical purification, isolation, and/or synthesis) surfactants, condensates, solvents and/or inhibitors.
- non-biologicale.g., produced by chemical purification, isolation, and/or synthesis
- surfactantse.g., condensates, solvents and/or inhibitors.
- Surfactantsare surface active agents having two functional groups, namely a hydrophilic (water-soluble) or polar group and a hydrophobic (oil-soluble) or non-polar group.
- the hydrophobic groupis usually a long hydrocarbon chain (C8-C18), which may or may not be branched, while the hydrophilic group is formed by moieties such as carboxylates, sulfates, sulfonates (anionic), alcohols, polyoxyethylenated chains (nonionic) and quaternary ammonium salts (cationic).
- Non-biological surfactantsinclude, but are not limited to: anionic surfactants, ammonium lauryl sulfate, sodium lauryl sulfate (also called SDS, sodium dodecyl sulfate), alkyl-ether sulfates sodium laureth sulfate (also known as sodium lauryl ether sulfate (SLES)), sodium myreth sulfate; docusates, dioctyl sodium sulfosuccinate, perfluorooctanesulfonate (PFOS), perfluorobutanesulfonate, linear alkylbenzene sulfonates (LABs), alkyl-aryl ether phosphates, alkyl ether phosphate; carboxylates, alkyl carboxylates (soaps), sodium stearate, sodium lauroyl sarcosinate, carboxylate-based fluorosurfactants,
- anionic surfactants
- hexadecyl trimethyl ammonium bromidecetyl trimethylammonium chloride (CTAC), cetylpyridinium chloride (CPC), benzalkonium chloride (BAC), benzethonium chloride (BZT), 5-Bromo-5-nitro-1,3-dioxane, dimethyldioctadecylammonium chloride, cetrimonium bromide, dioctadecyldi-methylammonium bromide (DODAB); zwitterionic (amphoteric) surfactants, sultaines CHAPS (3-[(3-Cholamidopropyl)dimethylammonio]-1-propanesulfonate), cocamidopropyl hydroxysultaine, betaines, cocamidopropyl betaine, phosphatidylserine, phosphatidylethanolamine, phosphatidylcholine, sphingomyelins; non
- Anionic surfactantscontain anionic functional groups at their head, such as sulfate, sulfonate, phosphate, and carboxylates.
- Prominent alkyl sulfatesinclude ammonium lauryl sulfate, sodium lauryl sulfate (also called SDS, sodium dodecyl sulfate) and the related alkyl-ether sulfates sodium laureth sulfate, also known as sodium lauryl ether sulfate (SLES), and sodium myreth sulfate.
- Carboxylatesare the most common surfactants and comprise the alkyl carboxylates (soaps), such as sodium stearate.
- Surfactants with cationic head groupsinclude: pH-dependent primary, secondary, or tertiary amines; octenidine dihydrochloride; permanently charged quaternary ammonium cations such as alkyltrimethylammonium salts: cetyl trimethylammonium bromide (CTAB) a.k.a.
- CABcetyl trimethylammonium bromide
- CTACcetyl trimethylammonium chloride
- CPCcetylpyridinium chloride
- BACbenzalkonium chloride
- BZTbenzethonium chloride
- DODABdioctadecyldi-methylammonium bromide
- Zwitterionic (amphoteric) surfactantshave both cationic and anionic centers attached to the same molecule.
- the cationic partis based on primary, secondary, or tertiary amines or quaternary ammonium cations.
- the anionic partcan be more variable and include sulfonates.
- Zwitterionic surfactantscommonly have a phosphate anion with an amine or ammonium, such as is found in the phospholipids phosphatidylserine, phosphatidylethanolamine, phosphatidylcholine, and sphingomyelins.
- a surfactant with a non-charged hydrophilic parte.g. ethoxylate, is non-ionic. Many long chain alcohols exhibit some surfactant properties.
- Condensatesare low-density mixtures of hydrocarbon liquids present as gaseous components in raw natural gas that will condense to liquid state depending on decrease in temperature and changes in pressure.
- Gas condensatesgenerally comprise propane, butane, pentane, hexane, and other compounds. Condensates can be used as chemical treatments, including as solvents, in paraffin removal in oil and gas wells and equipment.
- solvents and/or condensatesinclude, but are not limited to, aliphatic and/or terpenes, terpenoids, acetates, ionic liquids, alcohols, aromatic hydrocarbons, ketones, acetic acid, kerosene, gasoline, diesel, benzene, ethyl benzenes, propyl benzenes, butyl benzenes, toluene, ethyl toluenes, xylene, pentane, alkylene amines, dioxane, carbon disulfide, mesitylene, cumene, cymenes, saturated aliphatic and/or alicyclic hydrocarbons, naphtha, naphthenes, cyclohexane, decalin, tetralin, heptane, octane, cyclooctane, isooctane, cycl
- the subject methodscan be utilized alongside and/or in combination with enzyme treatments for hydrocarbon deposit removal and/or enhanced oil recovery.
- Enzymesare typically divided into six classes: oxidoreductases, transferases, hydrolases, lyases, isomerases and ligases. Each class is further divided into subclasses and by action.
- enzymes according to the subject inventioninclude, but are not limited to, proteases, amylases, glycosidases, cellulases, glucosidases, glucanases, galactosidases, moannosidases, sucrases, dextranases, hydrolases, methyltransferases, phosphorylases, dehydrogenases (e.g., glucose dehydrogenase, alcohol dehydrogenase), oxygenases (e.g., alkane oxygenases, methane monooxygenases, dioxygenases), hydroxylases (e.g., alkane hydroxylase), esterases, lipases, ligninases, mannanases, oxidases, laccases, tyrosinases, cytochrome P450 enzymes, peroxidases (e.g., chloroperoxidase and other haloperoxidasese), lactases
- microbial speciese.g., lipases from Bacillus subtilis, B. licheniformis, B. amyloliquefaciens, Serratia marcescens, Pseudomonas aeruginosa , and Staphylococcus aureus
- enzyme-based productsknown in the oil and gas industry.
- the subject inventionprovides methods for cultivation of microorganisms and production of microbial metabolites and/or other by-products of microbial growth.
- the subject inventionprovides materials and methods for the production of biomass (e.g., viable cellular material), extracellular metabolites (e.g. small molecules and excreted proteins), residual nutrients and/or intracellular components (e.g. enzymes and other proteins).
- biomasse.g., viable cellular material
- extracellular metabolitese.g. small molecules and excreted proteins
- residual nutrients and/or intracellular componentse.g. enzymes and other proteins.
- a microbe growth facilityproduces fresh, high-density microorganisms and/or microbial growth by-products of interest on a desired scale.
- the microbe growth facilitymay be located at or near the site of application, or at a different location.
- the facilityproduces high-density microbe-based compositions in batch, quasi-continuous, or continuous cultivation.
- the microbe growth facilities of the subject inventioncan be located at or near the location where the microbe-based product will be used (e.g., at or near an oil well)
- the microbe growth facilitymay be less than 300, 250, 200, 150, 100, 75, 50, 25, 15, 10, 5, 3, or 1 mile from the location of use.
- the microbe growth facilitiescan produce fresh, microbe-based compositions, comprising the microbes themselves, microbial metabolites, and/or other components of the medium in which the microbes are grown.
- the compositionscan have a high density of vegetative cells or a mixture of vegetative cells, spores, conidia, mycelia and/or other microbial propagules.
- the compositionscan be tailored for use at a specified location.
- the microbe growth facilityis located on, or near, a site where the microbe-based products will be used.
- the methods of the subject inventionharness the power of naturally-occurring local microorganisms and their metabolic by-products to improve oil production, transmission and/or refining.
- Local microbescan be identified based on, for example, salt tolerance, ability to grow at high temperatures, and the use of genetic identification of the sequences described herein.
- the microbe growth facilitiesprovide manufacturing versatility by their ability to tailor the microbe-based products to improve synergies with destination geographies.
- the microbe growth facilitiesmay operate off the grid by utilizing, for example, solar, wind and/or hydroelectric power.
- microbe-based compositionscan be produced in remote locations.
- the growth vessel used for growing microorganismscan be any fermenter or cultivation reactor for industrial use.
- the vesselmay have functional controls/sensors or may be connected to functional controls/sensors to measure important factors in the cultivation process, such as pH, oxygen, pressure, temperature, agitator shaft power, humidity, viscosity and/or microbial density and/or metabolite concentration.
- the vesselmay also be able to monitor the growth of microorganisms inside the vessel (e.g., measurement of cell number and growth phases).
- a daily samplemay be taken from the vessel and subjected to enumeration by techniques known in the art, such as dilution plating technique.
- Dilution platingis a simple technique used to estimate the number of microbes in a sample. The technique can also provide an index by which different environments or treatments can be compared.
- the cultivationutilizes a medium supplemented with a nitrogen source.
- the nitrogen sourcecan be, for example, potassium nitrate, ammonium nitrate ammonium sulfate, ammonium phosphate, ammonia, urea, and/or ammonium chloride. These nitrogen sources may be used independently or in a combination of two or more.
- the cultivationsupplies oxygenation to the growing culture.
- One embodimentutilizes slow motion of air to remove low-oxygen containing air and introduce oxygenated air.
- the oxygenated airmay be ambient air supplemented daily through mechanisms including impellers for mechanical agitation of the liquid, and air spargers for supplying bubbles of gas to the liquid for dissolution of oxygen into the liquid.
- the cultivationutilizes a medium supplemented with a carbon source.
- the carbon sourceis typically a carbohydrate, such as glucose, sucrose, lactose, fructose, trehalose, mannose, mannitol, and/or maltose; organic acids such as acetic acid, fumaric acid, citric acid, propionic acid, malic acid, malonic acid, and/or pyruvic acid; alcohols such as ethanol, isopropyl, propanol, butanol, pentanol, hexanol, isobutanol, and/or glycerol; fats and oils such as soybean oil, rice bran oil, canola oil, olive oil, corn oil, sesame oil, and/or linseed oil; etc.
- These carbon sourcesmay be used independently or in a combination of two or more.
- the methodcomprises use of two carbon sources, one of which is a saturated oil selected from canola, vegetable, corn, coconut, olive, or any other oil suitable for use in, for example, cooking.
- a saturated oilselected from canola, vegetable, corn, coconut, olive, or any other oil suitable for use in, for example, cooking.
- the saturated oilis 15% canola oil or discarded oil that has been used for cooking.
- the microorganismscan be grown on a solid or semi-solid substrate, such as, for example, corn, wheat, soybean, chickpeas, beans, oatmeal, pasta, rice, and/or flours or meals of any of these or other similar substances.
- a solid or semi-solid substratesuch as, for example, corn, wheat, soybean, chickpeas, beans, oatmeal, pasta, rice, and/or flours or meals of any of these or other similar substances.
- growth factors and trace nutrients for microorganismsare included in the medium. This is particularly preferred when growing microbes that are incapable of producing all of the vitamins they require.
- Inorganic nutrientsincluding trace elements such as iron, zinc, copper, manganese, molybdenum and/or cobalt may also be included in the medium.
- sources of vitamins, essential amino acids, and microelementscan be included, for example, in the form of flours or meals, such as corn flour, or in the form of extracts, such as yeast extract, potato extract, beef extract, soybean extract, banana peel extract, and the like, or in purified forms. Amino acids such as, for example, those useful for biosynthesis of proteins, can also be included.
- inorganic saltsmay also be included.
- Usable inorganic saltscan be potassium dihydrogen phosphate, dipotassium hydrogen phosphate, disodium hydrogen phosphate, magnesium sulfate, magnesium chloride, iron sulfate, iron chloride, manganese sulfate, manganese chloride, zinc sulfate, lead chloride, copper sulfate, calcium chloride, calcium carbonate, sodium chloride and/or sodium carbonate.
- These inorganic saltsmay be used independently or in a combination of two or more.
- the method for cultivationmay further comprise adding additional acids and/or antimicrobials in the liquid medium before and/or during the cultivation process.
- Antimicrobial agents or antibioticsare used for protecting the culture against contamination. Additionally, antifoaming agents may also be added to prevent the formation and/or accumulation of foam during cultivation.
- the pH of the mixtureshould be suitable for the microorganism of interest. Buffers, and pH regulators, such as carbonates and phosphates, may be used to stabilize pH near a preferred value. When metal ions are present in high concentrations, use of a chelating agent in the liquid medium may be necessary.
- the method for cultivation of microorganismsis carried out at about 5° to about 100° C., preferably, 15 to 60° C., more preferably, 25 to 50° C.
- the cultivationmay be carried out continuously at a constant temperature.
- the cultivationmay be subject to changing temperatures.
- the equipment used in the method and cultivation processis sterile.
- the cultivation equipmentsuch as the reactor/vessel may be separated from, but connected to, a sterilizing unit, e.g., an autoclave.
- the cultivation equipmentmay also have a sterilizing unit that sterilizes in situ before starting the inoculation.
- Aircan be sterilized by methods know in the art.
- the ambient aircan pass through at least one filter before being introduced into the vessel.
- the mediummay be pasteurized or, optionally, no heat at all added, where the use of low water activity and low pH may be exploited to control undesirable bacterial growth.
- the subject inventionprovides methods of producing a microbial metabolite by cultivating a microbe strain of the subject invention under conditions appropriate for growth and production of the metabolite; and, optionally, purifying the metabolite.
- the metaboliteis a biosurfactant.
- the metabolitemay also be, for example, solvents, acids, ethanol, lactic acid, manno-proteins, beta-glucan, proteins, amino acids, peptides, metabolic intermediates, polyunsaturated fatty acids, and lipids.
- the metabolite content produced by the methodcan be, for example, at least 20%, 30%, 40%, 50%, 60%, 70%, 80%, or 90%.
- the biomass content of the fermentation mediummay be, for example from 5 g/l to 180 g/l or more, or from 10 g/l to 150 g/l.
- the microbial growth by-product produced by microorganisms of interestmay be retained in the microorganisms or secreted into the growth medium.
- the method for producing microbial growth by-productmay further comprise steps of concentrating and purifying the microbial growth by-product of interest.
- the mediummay contain compounds that stabilize the activity of microbial growth by-product.
- the method for cultivation of microorganisms and production of the microbial by-productscan be performed in a batch, quasi-continuous, or continuous processes.
- all of the microbial cultivation compositionis removed upon the completion of the cultivation (e.g., upon, for example, achieving a desired cell density, or density of a specified metabolite).
- this batch procedurean entirely new batch is initiated upon harvesting of the first batch.
- biomass with viable cellsremains in the vessel as an inoculant for a new cultivation batch.
- the composition that is removedcan be a microbe-free medium or contain cells, spores, mycelia, conidia or other microbial propagules. In this manner, a quasi-continuous system is created.
- the methods of cultivationdo not require complicated equipment or high energy consumption.
- the microorganisms of interestcan be cultivated at small or large scale on site and utilized, even being still-mixed with their media.
- the microbial metabolitescan also be produced at large quantities at the site of need.
- the microbe-based productscan be generated locally, without resort to the microorganism stabilization, preservation, storage and transportation processes of conventional microbial production, a much higher density of live microbes, spores, mycelia, conidia or other microbial propagules can be generated, thereby requiring a smaller volume of the microbe-based product for use in the on-site application or which allows much higher density microbial applications where necessary to achieve the desired efficacy.
- Thisallows for a scaled-down bioreactor (e.g., smaller fermentation tank, smaller supplies of starter material, nutrients and pH control agents), which makes the system efficient.
- Local generation of the microbe-based productalso facilitates the inclusion of the growth medium in the product.
- the mediumcan contain agents produced during the fermentation that are particularly well-suited for local use.
- microbe-based products of the subject inventionare particularly advantageous compared to traditional products wherein cells, spores, mycelia, conidia and/or other microbial propagules have been separated from metabolites and nutrients present in the fermentation growth media. Reduced transportation times allow for the production and delivery of fresh batches of microbes and/or their metabolites at the time and volume as required by local demand.
- local microbe growth facilitiesprovide a solution to the current problem of relying on far-flung industrial-sized producers whose product quality suffers due to upstream processing delays, supply chain bottlenecks, improper storage, and other contingencies that inhibit the timely delivery and application of, for example, a viable, high cell- and/or propagule-count product and the associated growth medium and metabolites in which the microbes are originally grown.
- microbe-based productse.g., yeast fermentation products
- contaminantse.g., paraffin
- One microbe-based product of the subject inventionis simply the fermentation medium containing the microorganism and/or the microbial metabolites produced by the microorganism and/or any residual nutrients.
- the product of fermentationmay be used directly without extraction or purification. If desired, extraction and purification can be easily achieved using standard extraction and/or purification methods or techniques described in the literature.
- a first yeast fermentation productdesignated as “Star 3+,” can be obtained via cultivation of a yeast, e.g., Wickerhamomyces anomalus , using a modified form of solid state fermentation.
- the culturecan be grown on a substrate with ample surface area onto which the yeasts can attach and propagate, such as, for example, rice, soybeans, chickpeas, pasta, oatmeal or beans.
- the entire fermentation medium with yeast cells growing throughout, and any growth by-products thereofe.g., enzymes, solvents, and/or biosurfactants
- the culturecan be blended with the substrate, milled and/or micronized, and optionally, dried. This comprises the Star 3+ product.
- the compositionwhich can comprise 10 10 to 10 12 cells/gram, can be diluted, for example, up to 10, 50, 100, 500, or 1,000 times prior to being mixed with other components.
- the first yeast fermentation productis obtained using submerged fermentation, wherein the yeast fermentation product comprises liquid broth comprising cells and any yeast growth by-products.
- a liquid medium containing necessary sources of carbon, nitrogen, minerals and optionally, antimicrobial substances to prevent contaminating bacterial growthcan be used.
- the culturecan be grown with an additional carbon source, particularly, a saturated oil (e.g., 15% canola oil, or used cooking vegetable oil).
- a saturated oile.g., 15% canola oil, or used cooking vegetable oil.
- the pHbegins at 5.0-5.5, then decreases to 3.0-3.5, where it is stabilized.
- the fermentation broth with cells and yeast growth by-productswhich can be harvested after, for example, 24-72 hours of cultivation at 25-30° C., comprises this alternative form of the Star 3+ product.
- a second yeast fermentation productcan be obtained via submerged cultivation of a biosurfactant-producing yeast, e.g., Starmerella bombicola .
- This yeastis an effective producer of glycolipid biosurfactants, such as SLP.
- the fermentation broth after 5 days of cultivation at 25° C.can contain the yeast cell suspension and, for example, 150 g/L or more of SLP.
- the second yeast fermentationcan be further modified if less biosurfactant is desired in the composition.
- fermentation of S. bombicolaresults in separation of the SLP into a distinguishable layer.
- This SLP layercan be removed and the residual liquid and biomass, which can still contain 1-4 g/L of residual SLP, can then be utilized a in the subject composition.
- microorganisms in the microbe-based productmay be in an active or inactive form.
- the microbesare inactivated prior to adding to the compositions of the subject invention.
- microbe-based productsmay be used without further stabilization, preservation, and storage.
- direct usage of these microbe-based productspreserves a high viability of the microorganisms up until inactivation, reduces the possibility of contamination from foreign agents and undesirable microorganisms, and maintains the activity of the by-products of microbial growth.
- microbes and/or mediume.g., broth or solid substrate
- the microbes and/or mediume.g., broth or solid substrate
- the microbes and/or medium resulting from the microbial growthcan be removed from the growth vessel and transferred via, for example, piping for immediate use.
- the microbe-based productis simply the growth by-products of the microorganism.
- biosurfactants produced by a microorganismcan be collected from a submerged fermentation vessel in crude form, comprising, for example about 0.001% to about 99% pure biosurfactant in liquid broth.
- the microbe-based productcan be placed in containers of appropriate size, taking into consideration, for example, the intended use, the contemplated method of application, the size of the fermentation vessel, and any mode of transportation from microbe growth facility to the location of use.
- the containers into which the microbe-based composition is placedmay be, for example, from 1 gallon to 1,000 gallons or more. In other embodiments the containers are 2 gallons, 5 gallons, 25 gallons, or larger.
- the yeast fermentation product according to the subject compositioncomprises a yeast strain and/or growth by-products thereof.
- yeast fermentation products according to the subject inventioncan be superior to, for example, purified microbial metabolites alone, due to, for example, the advantageous properties of the yeast cell walls.
- These propertiesinclude high concentrations of mannoprotein as a part of yeast cell wall's outer surface (mannoprotein is a highly effective bioemulsifier) and the presence of biopolymer beta-glucan (an emulsifier) in yeast cell walls.
- the yeast fermentation productfurther can comprise biosurfactants in the culture, which are capable of reducing both surface and interfacial tension, and other metabolites (e.g., lactic acid, ethyl acetate, ethanol, etc.) in the culture.
- the yeast fermentation productUpon harvesting, for example, the yeast fermentation product, from the growth vessels, further components can be added as the harvested product is placed into containers and/or piped (or otherwise transported for use).
- the additivescan be, for example, buffers, carriers, other microbe-based compositions produced at the same or different facility, viscosity modifiers, preservatives, nutrients for microbe growth, tracking agents, solvents, biocides, other microbes and other ingredients specific for an intended use.
- suitable additiveswhich may be contained in the formulations according to the invention, include substances that are customarily used for such preparations.
- suitable additivesinclude surfactants, emulsifying agents, lubricants, buffering agents, solubility controlling agents, pH adjusting agents, preservatives, stabilizers and ultra-violet light resistant agents.
- the productmay further comprise buffering agents including organic and amino acids or their salts.
- buffersinclude citrate, gluconate, tartarate, malate, acetate, lactate, oxalate, aspartate, malonate, glucoheptonate, pyruvate, galactarate, glucarate, tartronate, glutamate, glycine, lysine, glutamine, methionine, cysteine, arginine and a mixture thereof.
- Phosphoric and phosphorous acids or their saltsmay also be used.
- Synthetic buffersare suitable to be used but it is preferable to use natural buffers such as organic and amino acids or their salts listed above.
- pH adjusting agentsinclude potassium hydroxide, ammonium hydroxide, potassium carbonate or bicarbonate, hydrochloric acid, nitric acid, sulfuric acid or a mixture.
- additional componentssuch as an aqueous preparation of a salt such as sodium bicarbonate or carbonate, sodium sulfate, sodium phosphate, sodium biphosphate, can be included in the formulation.
- a saltsuch as sodium bicarbonate or carbonate, sodium sulfate, sodium phosphate, sodium biphosphate
- the microbe-based productmay comprise medium in which the microbes were grown.
- the productmay be, for example, at least, by weight, 1%, 5%, 10%, 25%, 50%, 75%, or 100% growth medium.
- the amount of biomass in the product, by weightmay be, for example, anywhere from 0% to 100%, 10% to 90%, 20% to 80%, or 30% to 70%, inclusive of all percentages therebetween.
- the productcan be stored prior to use.
- the storage timeis preferably short.
- the storage timemay be less than 60 days, 45 days, 30 days, 20 days, 15 days, 10 days, 7 days, 5 days, 3 days, 2 days, 1 day, or 12 hours.
- the productis stored at a cool temperature such as, for example, less than 20° C., 15° C., 10° C., or 5° C.
- a biosurfactant compositioncan typically be stored at ambient temperatures.
- the subject productscan be used to simultaneously enhance oil recovery (e.g., by stimulating an oil well), while removing paraffin and other contaminants from oil production equipment and oil-bearing formations.
- microorganisms useful according to the subject inventioncan be, for example, bacteria, yeast and/or fungi. These microorganisms may be natural, or genetically modified microorganisms. For example, the microorganisms may be transformed with specific genes to exhibit specific characteristics.
- the microorganismsmay also be mutants of a desired strain.
- mutantmeans a strain, genetic variant or subtype of a reference microorganism, wherein the mutant has one or more genetic variations (e.g., a point mutation, missense mutation, nonsense mutation, deletion, duplication, frameshift mutation or repeat expansion) as compared to the reference microorganism. Procedures for making mutants are well known in the microbiological art. For example, UV mutagenesis and nitrosoguanidine are used extensively toward this end.
- the microorganismis any yeast or fungus, including, for example, Acaulospora, Aspergillus, Aureobasidium (e.g., A. pullulans ), Blakeslea, Candida (e.g., C. albicans, C. apicola ), Debaryomyces (e.g., D. hansenii ), Entomophihora, Fusarium, Hanseniaspora (e.g., H. uvarum ), Hansenula, Issatchenkia, Kluyveromyces, Mortierella, Mucor (e.g., M.
- yeast or fungusincluding, for example, Acaulospora, Aspergillus, Aureobasidium (e.g., A. pullulans ), Blakeslea, Candida (e.g., C. albicans, C. apicola ), Debaryomyces (e.g., D. hansenii ), Entomophihora
- Penicilliume.g., Penicillium, Phythium, Phycomyces, Pichia (e.g., P. anomala, P. guielliermondii, P. occidentalis, P. kudriavzevii ), Pseudozyma (e.g., P. aphidis ), Rhizopus, Saccharomyces ( S. cerevisiae, S. boulardii sequela, S. torula ), Starmerella (e.g., S. bombicola ), Torulopsis, Thraustochytrium, Trichoderma (e.g., T. reesei, T harzianum, T.
- Ustilagoe.g., U. maydis
- Wickerhamomycese.g., W. anomalus
- Williopsise.g., Z. bailii
- Zygosaccharomycese.g., Z. bailii
- the microbial strainis a Pichia yeast, or a related species selected from Wickerhamomyces anomalus ( Pichia anomala ), Meyerozyma guilliermondii ( Pichia guilliermondii ) and Pichia kudriavzevii.
- the yeast or fungusis Starmerella bombicola, Pseudozyma aphidis , or Saccharomyces cerevisiae.
- the yeastis Wickerhamomyces anomalus .
- W. anomalusproduces a killer toxin comprising exo- ⁇ -1,3-glucanase. Additionally, W. anomalus produces biosurfactants that are capable of reducing surface/interfacial tension of water, as well as various other useful solvents, enzymes and other metabolites, such as, for example, phytase, glycosidases, ethyl acetate, acetic acid, lactic acid, and ethanol.
- the yeastis Starmerella bombicola , which is an effective producer of, for example, glycolipid biosurfactants.
- the yeastis Meyerozyma guilliermondii , which is an effective producer of, for example, glycolipid biosurfactants and/or esterified fatty acid compounds.
- microbial strainscan be used in accordance with the subject invention, including, for example, any other yeast and/or fungal strains having high concentrations of mannoprotein and/or beta-glucan in their cell walls and/or that are capable of producing biosurfactants and other metabolites such as, e.g., lactic acid, ethyl acetate and ethanol.
- the first yeast fermentation product according to the subject inventioncan be obtained via cultivation of, e.g., Wickerhamomyces anomalus , using a solid or semi-solid substrate.
- corn flour, chickpeas, soybeans, rice or other similar foodstuff itemscan be mixed with nutrient medium seeded with, for example, 1 ⁇ 10 12 cells/ml of W anomalus .
- the yeast and any growth by-products thereofe.g., enzymes, solvents, and/or biosurfactants
- the yeastscan be inactivated by, for example, thermal means.
- the productcan be diluted by 10-1,000 times prior to mixing with other composition ingredients.
- the different strains of microbeare produced and stored separately and then mixed together prior to use.
- Aged sand used for crude oil recoveryis prepared by mixing sand with crude oil and “aging” the mixture for 3 days at 60° C. Six test tubes are filled with the mixture. The crude oil content in the sand is 18%, or an estimated 3.6 ml per tube. Each tube is treated with 25 mL of a treatment as follows:
- Treatment number 5recovered about 80% of the oil from the sand, with number 2 recovering about 55% of the oil.
- Crude oil precipitatesi.e., paraffin
- Crude oil precipitatesi.e., paraffin
- the sampleswere mixed and then chilled to allow for formation of the paraffin wax crystals, with examination of the samples for flow characteristics occurring at every ⁇ 3° C. temperature interval. The lowest temperature at which movement of the sample is observed is recorded as the pour point.
- the mixture of paraffin and treatment compositionseparated into a lower, solid paraffin portion and a top liquid portion.
- the liquid portioncomprising D-limonene and canola oil, separated from the mixture while it was being chilled and remained in liquid form at the ⁇ 3° C. temperature.
- Paraffinic Texas Permian crude that was treated with the composition of the subject inventionwas tested for pour point depression.
- the ASTM D5950 standard test method for pour point of petroleum products (automatic tilt method)was used.
- the resulting pour point valuewas about ⁇ 25° F., or about ⁇ 32° C.
- a hard, low-grade paraffin crudewas sampled from a well in Irion Country, Tex. and treated with two formulations (1 and 2) of the subject composition in test tubes. Three replicates (1, 1a, 1b) were performed using Formulation 1, and three replicates were performed using Formulation 2 (2, 2a, 2b).
- Formulation 1comprised: Star 3+ diluted; SLP 10 ml/L; turpentine 50 ml/L; monoammonium phosphate 10 g/L; sodium citrate 10 g/L.
- Formulation 2comprised: Star 3+ diluted; SLP 10 ml/L; turpentine 100 ml/L; monoammonium phosphate 10 g/L; sodium citrate 10 g/L.
- paraffin grade dispersal gradewas for each replicate after 2 hours and 4 hours, with grade 5 being fully dispersed paraffin. The results are reported in Tables 1 and 2, below. See also, FIGS. 2A-2B .
- a very hard paraffin crude (#1)was sampled from a well and treated with a formulation (Formulation 3) of a composition according to an embodiment of the subject invention. The results were compared to other standard paraffin dispersants. Multiple replicates were performed for each treatment.
- Formulation 3comprised: Star3+ in 0.1% oil, diluted; SLP 10 ml/L; dipentene 200 ml/L; sodium citrate 10 g/L; monoammonium phosphate 10 g/L; and purified MEL 5 ml/L.
- paraffin dispersal gradewas measured for each replicate. All five replicates of Formulation 3 treatment produced fully dispersed (grade 5) paraffin in only 1 hour.
- a hard paraffin crude(#2, less hard than #1) was sampled from a well, treated with Formulation 3 and compared to other standard paraffin treatments. Multiple replicates were performed for each treatment.
- paraffin dispersal gradewas measured for each replicate. All five replicates of Formulation 3 treatment produced fully dispersed (grade 5) paraffin by 2 hours. The results are reported in Table 4, below. See also, FIGS. 4A-4B .
- a hard paraffin crude(#3, less hard than #1 and #2) was sampled from a well, treated Formulation 3 and compared to other standard paraffin treatments. Multiple replicates were performed for each treatment.
- paraffin dispersal gradewas measured for each replicate. All five replicates of Formulation 3 treatment produced fully dispersed (grade 5) paraffin by 1 hour. The results are reported in Table 5, below. See also, FIGS. 5A-5B .
- FIG. 6shows the piece of casing before treatment ( 6 A) and after treatment ( 6 B).
- Gram-positive and Gram-negative bacterial strainswere cultivated in nutrient rich broth media with varying concentrations of a composition according to an embodiment of the subject invention in each respective flask (1, 5, and 10% v/v). Initial and final cell concentrations of each flask were calculated in colony forming unit/milliliter (CFU/ml).
- B. subtilis subtiliswas cultivated in a flask for 48 hours at 35° C. in nutrient rich broth to allow for maximal cell concentrations to be reached. 0.1 ml of the mature culture was spread onto 4 sterile nutrient agar plates.
- FIGS. 8A-8Cshow the treatment plates versus untreated controls. Bacterial growth inhibition was clear at the site of treatment application, with a greater area of inhibition corresponding to increasing percent volume of composition.
- B. subtilis subtiliswas allowed to cultivate and form a biofilm after 24 hours of incubation at 35° C. on a nutrient agar plate. Once the biofilm was established, 0.05 ml of a composition according to an embodiment of the subject invention was directly added to the surface of the biofilm at the center of the agar plate to test for biofilm degradation. As shown in FIGS. 9A-9B , initial signs of biofilm degradation were observed within 16 hours.
- B. subtilis subtiliswas spread onto 4 agar plates. Once the spread was visibly dry, a piece of agar was removed from the center of each agar plate and a composition according to an embodiment of the subject invention was added to the “well” that was created. The treatment soaked into the surrounding agar.
- FIGS. 10A-10Cshow the treatment plates versus untreated controls. A circular area of thinning biofilm was observed around the agar well where treatment had soaked into the agar.
Landscapes
- Chemical & Material Sciences (AREA)
- Engineering & Computer Science (AREA)
- Life Sciences & Earth Sciences (AREA)
- General Life Sciences & Earth Sciences (AREA)
- Organic Chemistry (AREA)
- Materials Engineering (AREA)
- Oil, Petroleum & Natural Gas (AREA)
- Geology (AREA)
- Mining & Mineral Resources (AREA)
- Physics & Mathematics (AREA)
- Environmental & Geological Engineering (AREA)
- Fluid Mechanics (AREA)
- Geochemistry & Mineralogy (AREA)
- Lubricants (AREA)
- Production Of Liquid Hydrocarbon Mixture For Refining Petroleum (AREA)
Abstract
Description
- Z=O
- R1=C6to C22saturated or unsaturated hydrocarbon, or an epoxide, or cyclopropane thereof
- Y1=H, C1-C5hydrocarbon, or hydroxyl at any position along R1
- Y2=H, C1-C5hydrocarbon, or hydroxyl at any position along R1
- Y3=H, C1-C5hydrocarbon, or hydroxyl at any position along R2
- Y4=H, C1-C5hydrocarbon, or hydroxyl at any position along R2
- R2=C1-C10saturated or unsaturated, branched or unbranched, hydrocarbon.
- Y1=H, C1-C5hydrocarbon, or hydroxyl at any position along R1
- Y2=H, C1-C5hydrocarbon, or hydroxyl at any position along R1
- Y3=H, C1-C5hydrocarbon, or hydroxyl at any position along R2
- Y4=H, C1-C5hydrocarbon, or hydroxyl at any position along R2
- R2=C1-C10saturated or unsaturated, branched or unbranched, hydrocarbon.
- 1. SLP (50 ml/L); dipentene (50 ml/L); primary amyl acetate (50 ml/L); monoammonium phosphate (10 g/L); sodium citrate (10 g/L); remainder of volume=Star3+.
- 2. SLP (25 ml/L); dipentene (50 ml/L); primary amyl acetate (50 ml/L); monoammonium phosphate (10 g/L); sodium citrate (10 g/L); remainder of volume=Star3+.
- 3. SLP (50 ml/L); dipentene (50 ml/L); primary amyl acetate (50 ml/L); monoammonium phosphate (10 g/L); sodium citrate (10 g/L); isopropyl alcohol (4 ml/L); remainder of volume=Star3+.
- 4. Same as #3.
- 5. (Positive control) SLP (5 ml/L); ammonium hydroxide (3 ml/L); isopropyl alcohol (4 ml/L); monoammonium phosphate (2 g/L); mixture of chelating agents (10 g/L); remainder of volume=water.
- 6. Water.
| TABLE 1 |
| Increase in paraffin grade over 4 hours when treated with |
| Grade | ||
| Time: |
| 1 hr. | 2 hr. | 3 hr. | 4 hr. | |||
| 1 | 4 | 5 | ||||
| Formulation | 1 | 4 | 5 | |||
| Formulation | 1 | 4 | 5 | |||
| TABLE 2 |
| Increase in paraffin grade over 4 hours when treated with |
| Formulation 2. |
| Grade | ||
| Time: |
| 1 hr. | 2 hr. | 3 hr. | 4 hr. | ||
| 2 | Formulation 2 | 4 | 5 | ||
| 2a | Formulation 2 | 4 | 5 | ||
| 2b | Formulation 2 | 4 | 5 | ||
| TABLE 3 |
| Grade | ||||
| Time: | ||||
| 1 hr. | ||||
| Formulation | 3 | 5 | ||
| Formulation | 3 | 5 | ||
| 1c | 5 | |||
| Formulation | 3 | 5 | ||
| Formulation | 3 | 5 | ||
| 1a | 100 | 0 | ||
| 1b | 100 | 0 | ||
| 1a | 100% Xylene | 3.5 | ||
| 1b | 100 | 5 | ||
| 1a | 100 | 3 | ||
| 1b | 100% Kerosene | 4 | ||
| 1a | 100% Pentane | 4 | ||
| 1b | 100 | 5 | ||
| 1a | Unknown Dispersant A | 2 | ||
| 1b | Unknown Dispersant A | 2 | ||
| 1c | Unknown Dispersant A | 2 | ||
| 1a | 1 | |||
| 1b | 1 | |||
| 1c | 1 | |||
| 1a | 1 | |||
| 1b | 1 | |||
| 1c | 1 | |||
| 1a | Condensate | 4 | ||
| Condensate | 5 | |||
| TABLE 4 |
| Paraffin #2 dispersal grade over 2 hours. |
| Grade | |||
| Time: |
| 1 hr. | 2 hr. | ||||
| Formulation | 3 | 4.5 | 5 | ||
| Formulation | 3 | 5 | |||
| 2c | 4 | 5 | |||
| Formulation | 3 | 4.5 | 5 | ||
| Formulation | 3 | 3.5 | 5 | ||
| 2a | 100 | 0 | 0 | ||
| 2b | 100 | 0 | 0 | ||
| 2a | 100% Xylene | 4 | 5 | ||
| 2b | 100% Xylene | 4 | 5 | ||
| 2a | 100% Kerosene | 3.5 | 4.5 | ||
| 2b | 100% Kerosene | 3.5 | 5 | ||
| 2a | 100% Pentane | 4.5 | 5 | ||
| 2b | 100 | 5 | |||
| 2a | Unknown Dispersant A | 2 | 2 | ||
| 2b | Unknown Dispersant A | 2 | 2 | ||
| 2c | Unknown Dispersant A | 2 | 2 | ||
| 2a | Unknown Dispersant B | 2 | 2 | ||
| 2b | Unknown Dispersant B | 2 | 2 | ||
| 2c | Unknown Dispersant B | 2 | 2 | ||
| 2a | Unknown Dispersant C | 2 | 2 | ||
| 2b | Unknown Dispersant C | 2 | 2 | ||
| 2c | Unknown Dispersant C | 2 | 2 | ||
| Condensate | 5 | ||||
| Condensate | 5 | ||||
| TABLE 5 |
| Grade | ||||
| Time: | ||||
| 1 hr. | ||||
| Formulation | 3 | 5 | ||
| Formulation | 3 | 5 | ||
| 3c | Foimulation 3 | 5 | ||
| Formulation | 3 | 5 | ||
| Formulation | 3 | 5 | ||
| 3a | 100 | 0 | ||
| 3b | 100 | 0 | ||
| 3a | 100 | 5 | ||
| 3b | 100 | 5 | ||
| 3a | 100% Kerosene | 4.5 | ||
| 3b | 100 | 5 | ||
| 3a | 100 | 5 | ||
| 3b | 100 | 5 | ||
| 3a | 3 | |||
| 3b | 3 | |||
| 3c | 3 | |||
| 3a | Unknown Dispersant B | 3.5 | ||
| 3b | Unknown Dispersant B | 3.5 | ||
| 3c | Unknown Dispersant B | 3.5 | ||
| 3a | Unknown Dispersant C | 2 | ||
| 3b | Unknown Dispersant C | 2 | ||
| 3c | Unknown Dispersant C | 2 | ||
| Condensate | 5 | |||
| Condensate | 5 | |||
| TABLE 6 |
| Bacterial inhibition results, Gram-negative bacteria. |
| 0 | 24 hr | ||
| Sample | CFU/ml | CFU/ml | Fold Increase |
| B. thailendensis control | 3.6 × 106 | 9.0 × 109 | 2,500X |
| B. thailendensis + 1% | 3.7 × 106 | 5.0 x 109 | 1,350X |
| Composition | |||
| B. thailendensis + 5% | 2.0 × 106 | 4.0 × 108 | 200X |
| Composition | |||
| B. thailendensis + 10% | 2.1 × 106 | 3.8 × 106 | 2X |
| Composition | |||
| TABLE 7 |
| Bacterial inhibition results, Gram-positive bacteria. |
| 0 | 72 hr | ||
| Sample | CFU/ml | CFU/ml | Fold Increase |
| B1 Control | 2.1 × 106 | 7.0 × 107 | 33X |
| B1 + 1% Composition | 9.6 × 105 | 5.0 × 106 | 5.2X |
| B1 + 5% Composition | 1.4 × 106 | 4.0 × 106 | 4X |
| B1 + 10% | 1.2 × 106 | 2.0 × 104 | −60X |
| Composition | |||
Claims (19)
Priority Applications (1)
| Application Number | Priority Date | Filing Date | Title |
|---|---|---|---|
| US17/052,181US11434415B2 (en) | 2018-04-30 | 2019-04-30 | Compositions and methods for paraffin liquefaction and enhanced oil recovery in oil wells and associated equipment |
Applications Claiming Priority (8)
| Application Number | Priority Date | Filing Date | Title |
|---|---|---|---|
| US201862664613P | 2018-04-30 | 2018-04-30 | |
| US201862682462P | 2018-06-08 | 2018-06-08 | |
| US201862691098P | 2018-06-28 | 2018-06-28 | |
| US201862719734P | 2018-08-20 | 2018-08-20 | |
| US201862743815P | 2018-10-10 | 2018-10-10 | |
| US201962805539P | 2019-02-14 | 2019-02-14 | |
| US17/052,181US11434415B2 (en) | 2018-04-30 | 2019-04-30 | Compositions and methods for paraffin liquefaction and enhanced oil recovery in oil wells and associated equipment |
| PCT/US2019/029870WO2019213055A1 (en) | 2018-04-30 | 2019-04-30 | Compositions and methods for paraffin liquefaction and enhanced oil recovery in oil wells and associated equipment |
Related Parent Applications (1)
| Application Number | Title | Priority Date | Filing Date |
|---|---|---|---|
| PCT/US2019/029870A-371-Of-InternationalWO2019213055A1 (en) | 2018-04-30 | 2019-04-30 | Compositions and methods for paraffin liquefaction and enhanced oil recovery in oil wells and associated equipment |
Related Child Applications (1)
| Application Number | Title | Priority Date | Filing Date |
|---|---|---|---|
| US17/877,902ContinuationUS11891567B2 (en) | 2018-04-30 | 2022-07-30 | Compositions and methods for paraffin liquefaction and enhanced oil recovery in oil wells and associated equipment |
Publications (2)
| Publication Number | Publication Date |
|---|---|
| US20210301191A1 US20210301191A1 (en) | 2021-09-30 |
| US11434415B2true US11434415B2 (en) | 2022-09-06 |
Family
ID=68386733
Family Applications (4)
| Application Number | Title | Priority Date | Filing Date |
|---|---|---|---|
| US17/052,181ActiveUS11434415B2 (en) | 2018-04-30 | 2019-04-30 | Compositions and methods for paraffin liquefaction and enhanced oil recovery in oil wells and associated equipment |
| US17/877,902ActiveUS11891567B2 (en) | 2018-04-30 | 2022-07-30 | Compositions and methods for paraffin liquefaction and enhanced oil recovery in oil wells and associated equipment |
| US18/418,547ActiveUS12173230B2 (en) | 2018-04-30 | 2024-01-22 | Compositions and methods for paraffin liquefaction and enhanced oil recovery in oil wells and associated equipment |
| US19/000,993PendingUS20250129287A1 (en) | 2018-04-30 | 2024-12-24 | Compositions and Methods for Paraffin Liquefaction and Enhanced Oil Recovery in Oil Wells and Associated Equipment |
Family Applications After (3)
| Application Number | Title | Priority Date | Filing Date |
|---|---|---|---|
| US17/877,902ActiveUS11891567B2 (en) | 2018-04-30 | 2022-07-30 | Compositions and methods for paraffin liquefaction and enhanced oil recovery in oil wells and associated equipment |
| US18/418,547ActiveUS12173230B2 (en) | 2018-04-30 | 2024-01-22 | Compositions and methods for paraffin liquefaction and enhanced oil recovery in oil wells and associated equipment |
| US19/000,993PendingUS20250129287A1 (en) | 2018-04-30 | 2024-12-24 | Compositions and Methods for Paraffin Liquefaction and Enhanced Oil Recovery in Oil Wells and Associated Equipment |
Country Status (3)
| Country | Link |
|---|---|
| US (4) | US11434415B2 (en) |
| CA (1) | CA3098893A1 (en) |
| WO (1) | WO2019213055A1 (en) |
Cited By (1)
| Publication number | Priority date | Publication date | Assignee | Title |
|---|---|---|---|---|
| US20220372364A1 (en)* | 2018-04-30 | 2022-11-24 | Locus Oil Ip Company, Llc | Compositions and Methods for Paraffin Liquefaction and Enhanced Oil Recovery in Oil Wells and Associated Equipment |
Families Citing this family (17)
| Publication number | Priority date | Publication date | Assignee | Title |
|---|---|---|---|---|
| WO2019094615A1 (en) | 2017-11-08 | 2019-05-16 | Locus Oil Ip Company, Llc | Multifunctional composition for enhanced oil recovery, improved oil quality and prevention of corrosion |
| WO2020028253A1 (en) | 2018-07-30 | 2020-02-06 | Locus Oil Ip Company, Llc | Compositions and methods for enhanced oil recovery from low permeability formations |
| US11447684B2 (en) | 2018-08-20 | 2022-09-20 | Locus Oil Ip Company, Llc | Methods for paraffin removal and extended post-primary oil recovery |
| CN112159649B (en)* | 2020-08-07 | 2023-02-24 | 长江大学 | Biochemical viscosity reducer for thickened oil and preparation method thereof |
| CN114058351A (en)* | 2020-08-10 | 2022-02-18 | 中国石油化工股份有限公司 | Composite biological thickened oil viscosity reducer and preparation method and application thereof |
| CA3203187A1 (en) | 2021-04-06 | 2022-10-13 | Desmond Alexander SOMERVILLE | Lignin-based fracturing fluids and related methods |
| EP4206148A1 (en)* | 2021-12-29 | 2023-07-05 | Sanipur S.p.A. | Sanitization method and related formulation |
| US12139662B2 (en)* | 2022-03-17 | 2024-11-12 | Baker Hughes Oilfield Operations Llc | Synergistic corrosion inhibitor blends |
| WO2024196346A1 (en)* | 2023-03-17 | 2024-09-26 | Baker Hughes Oilfield Operations Llc | Synergistic corrosion inhibitor blends |
| EP4269530B1 (en)* | 2022-04-28 | 2024-11-20 | Evonik Operations GmbH | Multifunctional wax dispersant for subterranean chemical applications |
| EP4269531B1 (en) | 2022-04-28 | 2024-09-11 | Evonik Operations GmbH | Multifunctional wax dispersant for subterranean chemical applications |
| CN114958820B (en)* | 2022-05-11 | 2023-10-31 | 西南石油大学 | Water-soluble natural wax-dissolving agent and preparation method and application thereof |
| CN115010333B (en)* | 2022-06-27 | 2023-09-15 | 郑州大学 | Oily sludge cleaning fluid and oily sludge treatment method |
| WO2024030816A1 (en)* | 2022-08-03 | 2024-02-08 | Locus Solutions Ipco, Llc | Compositions and methods for cleaning high viscosity substances from storage and transport vessels |
| WO2025064524A1 (en)* | 2023-09-19 | 2025-03-27 | Locus Solutions Ipco, Llc | Contaminant precipitation compositions and methods of use |
| WO2025104445A1 (en)* | 2023-11-15 | 2025-05-22 | Bachman Services LLC | Method of cleaning |
| US12421441B1 (en)* | 2025-05-19 | 2025-09-23 | King Fahd University Of Petroleum And Minerals | Method for microbially enhanced oil recovery |
Citations (124)
| Publication number | Priority date | Publication date | Assignee | Title |
|---|---|---|---|---|
| US3191676A (en) | 1962-11-14 | 1965-06-29 | Pan American Petroleum Corp | Use of phosphates in a waterflooding process |
| US3581824A (en) | 1969-12-17 | 1971-06-01 | Mobil Oil Corp | Oil recovery process using an ionic polysaccharide thickening agent |
| US3871956A (en) | 1970-06-03 | 1975-03-18 | Bioteknika International | Microbial degradation of petroleum |
| US4369125A (en) | 1977-09-12 | 1983-01-18 | C E C A-S.A. | Gelling compositions having a base of galactomannans and xanthan |
| US4450908A (en) | 1982-04-30 | 1984-05-29 | Phillips Petroleum Company | Enhanced oil recovery process using microorganisms |
| US4487262A (en) | 1982-12-22 | 1984-12-11 | Mobil Oil Corporation | Drive for heavy oil recovery |
| US4522261A (en) | 1983-04-05 | 1985-06-11 | The Board Of Regents For The University Of Oklahoma | Biosurfactant and enhanced oil recovery |
| US4561501A (en) | 1983-06-28 | 1985-12-31 | Phillips Petroleum Company | Surfactant oil recovery systems and recovery of oil therewith |
| US4793826A (en) | 1984-09-24 | 1988-12-27 | Petroleum Fermentations N.V. | Bioemulsifier-stabilized hydrocarbosols |
| US4905761A (en) | 1988-07-29 | 1990-03-06 | Iit Research Institute | Microbial enhanced oil recovery and compositions therefor |
| US5152907A (en) | 1982-09-28 | 1992-10-06 | Amoco Corporation | Solvent systems for use in oil and gas wells |
| US5156652A (en) | 1986-12-05 | 1992-10-20 | Canadian Occidental Petroleum Ltd. | Low-temperature pipeline emulsion transportation enhancement |
| US5165477A (en) | 1990-12-21 | 1992-11-24 | Phillips Petroleum Company | Enzymatic decomposition of drilling mud |
| US5284576A (en) | 1989-08-01 | 1994-02-08 | Petrolite Corporation | Method of scavenging hydrogen sulfide from hydrocarbons |
| US5869325A (en) | 1996-03-22 | 1999-02-09 | Atlantic Richfield Company | Use of bacteria to break gels used in well treatment fluids |
| US6033901A (en) | 1994-04-11 | 2000-03-07 | Aplc, Inc. | System and process for in tank treatment of crude oil sludges to recover hydrocarbons and aid in materials separation |
| US20010056047A1 (en) | 2000-03-28 | 2001-12-27 | Georg Meine | Cleaning of fruit, vegetables, and meats |
| US20040171512A1 (en) | 2001-06-27 | 2004-09-02 | Taro Furuta | Low-foaming detergent compositions |
| US20040231845A1 (en) | 2003-05-15 | 2004-11-25 | Cooke Claude E. | Applications of degradable polymers in wells |
| US6942037B1 (en) | 2002-08-15 | 2005-09-13 | Clariant Finance (Bvi) Limited | Process for mitigation of wellbore contaminants |
| US20060219409A1 (en) | 2005-03-29 | 2006-10-05 | Dyer Richard J | Method for simultaneous removal of asphaltine, and/or paraffin and scale from producing oil wells |
| US20070092930A1 (en) | 2003-07-14 | 2007-04-26 | The Energy And Resources Institute | Process for enhanced recovery of crude oil from oil wells using novel microbial consortium |
| US7216705B2 (en)* | 2005-02-22 | 2007-05-15 | Halliburton Energy Services, Inc. | Methods of placing treatment chemicals |
| US20070125536A1 (en) | 2005-12-07 | 2007-06-07 | Andrew Acock | Method to Improve the Injectivity of Fluids and Gases Using Hydraulic Fracturing |
| US20070151726A1 (en) | 2005-03-16 | 2007-07-05 | Baker Hughes Incorporated | Methods and Compositions for Diverting Acid Fluids in Wellbores |
| WO2007129332A1 (en) | 2006-05-05 | 2007-11-15 | Halliburton Energy Services, Inc. | Compositions and methods for removal of asphaltenes from a portion of a wellbore or subterranean formation |
| US20080139412A1 (en)* | 2006-12-06 | 2008-06-12 | Fuller Michael J | Method for Treating a Subterranean Formation |
| US20080167445A1 (en) | 2007-01-04 | 2008-07-10 | Carl Walter Podella | Enhanced oil recovery compositions comprising proteins and surfactants and methods of using the same |
| US20080280789A1 (en) | 2007-05-10 | 2008-11-13 | Halliburton Energy Services, Inc. | Methods for stimulating oil or gas production using a viscosified aqueous fluid with a chelating agent to remove scale from wellbore tubulars or subsurface equipment |
| US20080302531A1 (en) | 2007-06-09 | 2008-12-11 | Oil Chem Technologies | Process for recovering oil from subterranean reservoirs |
| GB2450204A (en) | 2007-05-11 | 2008-12-17 | Clearwater Int Llc | Reducing the viscosity of a fracturing fluid using microbes |
| US7472747B1 (en) | 2007-08-01 | 2009-01-06 | Savannah River Nuclear Solutions, Llc | Biological enhancement of hydrocarbon extraction |
| US20090029879A1 (en) | 2007-07-12 | 2009-01-29 | Glori Oil Limited | Process for enhanced oil recovery using a microbial consortium |
| US20100044031A1 (en) | 2008-08-20 | 2010-02-25 | E. I. Dupont De Nemours And Company | Method for identification of novel anaerobic denitrifying bacteria utilizing petroleum components as sole carbon source |
| US7677673B2 (en) | 2006-09-26 | 2010-03-16 | Hw Advanced Technologies, Inc. | Stimulation and recovery of heavy hydrocarbon fluids |
| US7681638B2 (en) | 2007-06-15 | 2010-03-23 | Glori Oil Limited | Wellbore treatment for reducing wax deposits |
| US20100163230A1 (en) | 2007-06-26 | 2010-07-01 | Hans Kristian Kotlar | Method of enhancing oil recovery |
| JP2010200695A (en) | 2009-03-04 | 2010-09-16 | National Institute Of Advanced Industrial Science & Technology | Method for producing biosurfactant |
| WO2010111226A2 (en) | 2009-03-23 | 2010-09-30 | Yale University Office Of Cooperative Research | A composition and method for inhibiting agglomeration of hydrates in pipelines |
| WO2011008570A2 (en) | 2009-07-16 | 2011-01-20 | Dow Global Technologies, Inc. | Sulfonate surfactants and methods of preparation and use |
| US20110139262A1 (en) | 2009-12-15 | 2011-06-16 | Instituto Mexicano Del Petroleo | Process of preparing improved heavy and extra heavy crude oil emulsions by use of biosurfactants in water and product thereof |
| US20110290482A1 (en) | 2010-05-25 | 2011-12-01 | Board Of Regents, The University Of Texas System | Surfactant-Less Alkaline-Polymer Formulations for Recovering Reactive Crude Oil |
| CN102352227A (en) | 2011-08-08 | 2012-02-15 | 中国海洋石油总公司 | Lipopeptide biosurfactant, preparation method thereof, and application thereof |
| US20120037368A1 (en) | 2010-08-12 | 2012-02-16 | Conocophillips Company | Controlled release proppant |
| US20120055685A1 (en) | 2010-05-21 | 2012-03-08 | James Kenneth Sanders | Methods for increasing oil production |
| CN102399547A (en) | 2011-10-31 | 2012-04-04 | 湖州紫金生物科技有限公司 | Application of rhamnolipid as crude oil pipeline drag reducer and viscosity reducer |
| US20120122740A1 (en) | 2010-11-12 | 2012-05-17 | Instituto Mexicano Del Petroleo | Heavy oil recovery process using extremophile anaerobic indigenous microorganisms |
| US8188012B2 (en) | 2009-09-10 | 2012-05-29 | Board Of Regents, The University Of Texas System | Process of using hard brine at high alkalinity for enhanced oil recovery (EOR) applications |
| US20120247763A1 (en)* | 2011-04-01 | 2012-10-04 | Solazyme, Inc. | Biomass-based oil field chemicals |
| US20120292022A1 (en) | 2010-11-22 | 2012-11-22 | E. I. Du Pont De Nemours And Company | Composition for improving oil recovery including n-lauroyl amino acid-based compounds and microbes |
| US8316933B2 (en) | 2009-08-28 | 2012-11-27 | Geo Fossil Fuels Llc | Microbial enhanced oil recovery methods |
| US20130020082A1 (en) | 2011-04-05 | 2013-01-24 | Lumsden Charles A | Method and compositions for enhanced oil recovery |
| CN102925397A (en) | 2012-11-23 | 2013-02-13 | 天津亿利科能源科技发展股份有限公司 | Mixed bacterial agent for reducing viscosity of thick oil, as well as preparation method and use thereof |
| US20130048282A1 (en)* | 2011-08-23 | 2013-02-28 | David M. Adams | Fracturing Process to Enhance Propping Agent Distribution to Maximize Connectivity Between the Formation and the Wellbore |
| US20130062053A1 (en) | 2011-02-25 | 2013-03-14 | William J. Kohr | Alkaline microbial enhanced oil recovery |
| WO2013110132A1 (en) | 2012-01-27 | 2013-08-01 | Gfs Corporation Aus Pty Ltd | Method of producing biosurfactants |
| US20130264060A1 (en) | 2010-12-17 | 2013-10-10 | Akzo Nobel Chemicals International B.V. | Fluid suitable for treatment of carbonate formations containing a chelating agent |
| WO2013157921A1 (en) | 2012-04-20 | 2013-10-24 | Bci Chemical Corporation Sdn. Bhd. | Oil recovery from oil sludge with nanoemulsion surfactant |
| US20130319656A1 (en) | 2010-10-06 | 2013-12-05 | Trican Well Service Ltd. | Enzyme breakers and methods for fluid systems |
| CN103449696A (en) | 2012-06-04 | 2013-12-18 | 江苏博大环保股份有限公司 | Method for improving oil sludge separating and processing efficiency and bacterial strain used for method |
| CN103614131A (en) | 2013-12-12 | 2014-03-05 | 大连奥普森生物工程有限公司 | Biochemical anti-salt anti-high temperature oil displacement viscosity reducer and preparation method thereof |
| US20140073541A1 (en) | 2011-05-16 | 2014-03-13 | Stepan Company | Surfactants for enhanced oil recovery |
| US20140256600A1 (en)* | 2013-03-08 | 2014-09-11 | Solazyme, Inc. | Oleaginous Microbial Lubricants |
| US20140273150A1 (en) | 2013-03-15 | 2014-09-18 | Janet Angel | Compositions and Methods of Use |
| US20140305649A1 (en)* | 2012-04-12 | 2014-10-16 | Hongxin Tang | Submicron particles surfactant method for improved oil recovery from subterranean reservoirs |
| CN104109646A (en) | 2014-06-23 | 2014-10-22 | 中国石油化工股份有限公司 | Slime reducing agent suitable for heavy oil wells with different mineralization and application |
| US20140315765A1 (en) | 2013-04-22 | 2014-10-23 | Hulliburton Energy Services, Inc. | Treatment of a subterranean formation with composition including a microorganism or compound generated by the same |
| US20140323757A1 (en) | 2013-04-30 | 2014-10-30 | Gyeongbuk Institute of Marine Bio-industry | Biosurfactant Isolated from Yeast |
| US20140332212A1 (en)* | 2011-11-30 | 2014-11-13 | Verutek Technologies, Inc. | Compositions and methods for enhanced hydrocarbon recovery |
| US20140360727A1 (en) | 2013-06-07 | 2014-12-11 | Shell Oil Company | Remediation of asphaltene-induced plugging of an oil-bearing formation |
| KR101481459B1 (en) | 2014-03-07 | 2015-01-13 | 한국지질자원연구원 | Bitumen mining method of oil sand using biological treatment |
| WO2015093934A1 (en) | 2013-12-19 | 2015-06-25 | Bci Chemical Corporation Sdn Bhd | A method of treating oily solid particles |
| US20150259642A1 (en) | 2014-03-06 | 2015-09-17 | Indian Institute Of Technology Madras | Methods and compositions for degrading oil sludge |
| CN104974952A (en) | 2015-05-29 | 2015-10-14 | 苏州泽方新能源技术有限公司 | Mixed bacteria producing biological surfactant, and screening method thereof |
| US20150300139A1 (en) | 2014-04-21 | 2015-10-22 | Baker Hughes Incorporated | Method of using sophorolipids in well treatment operations |
| WO2015167864A1 (en) | 2014-05-01 | 2015-11-05 | Exxonmobil Research And Engineering Company | Method and system of upgrading heavy oils in the presence of hydrogen and a dispersed catalyst |
| US20160002521A1 (en)* | 2014-07-03 | 2016-01-07 | Solazyme, Inc. | Lubricants and wellbore fluids |
| JP2016000017A (en) | 2014-06-12 | 2016-01-07 | 花王株式会社 | Method of producing sophorolipid |
| US20160145487A1 (en) | 2013-09-11 | 2016-05-26 | Halliburton Energy Services, Inc. | Asphaltene-dissolving oil-external emulsion for acidization and methods of using the same |
| US20160160111A1 (en) | 2013-12-13 | 2016-06-09 | Halliburton Energy Services, Inc. | Methods and systems for removing geothermal scale |
| CN105753283A (en) | 2016-03-14 | 2016-07-13 | 北京华纳斯科技有限公司 | Method of utilizing biosurfactant and microbial agent to treat oil-containing sediment |
| US20160222280A1 (en) | 2013-09-12 | 2016-08-04 | Geo Fossil Fuels, Llc | Microbial enhanced oil recovery method |
| US9422470B2 (en) | 2011-09-15 | 2016-08-23 | Multi-Chem Group, Llc | Method for selection of surfactants in well stimulation |
| US20160251565A1 (en) | 2013-11-05 | 2016-09-01 | Kaneka Corporation | Method for producing hydrocarbon fluid from hydrocarbon fluid-rich shale |
| US9441115B2 (en) | 2011-11-14 | 2016-09-13 | Tantz Environmental Technologies Ltd. | Aqueous phase pore sealing agent imroving PCB coating oxidation-resistant and corrosion-resistant properties and method for using same |
| US20160333258A1 (en) | 2015-05-13 | 2016-11-17 | Preferred Technology, Llc | Hydrophobic Coating of Particulates for Enhanced Well Productivity |
| WO2016196680A1 (en) | 2015-06-01 | 2016-12-08 | Robert Caron | Biofilm control and frack fluid production using bacillus subtilis activated with gfak |
| US9550937B2 (en) | 2014-07-31 | 2017-01-24 | Baker Hughes Incorporated | Methods and compositions for decreasing the viscosity of hydrocarbon-based fluids during refining |
| US20170037301A1 (en) | 2014-05-30 | 2017-02-09 | Halliburton Energy Services, Inc. | Polymeric surfactant containing a protein head group and lipid tail group |
| WO2017040903A1 (en) | 2015-09-02 | 2017-03-09 | Chevron U.S.A. Inc. | Enhanced oil recovery compositions and methods thereof |
| WO2017044953A1 (en) | 2015-09-10 | 2017-03-16 | Locus Solutions, Llc | Enhanced microbial production of biosurfactants and other products, and uses thereof |
| US20170138135A1 (en) | 2015-11-18 | 2017-05-18 | Meshari Almutairi | System and method for remediation of oil-contaminated sand |
| US9683164B2 (en) | 2014-04-21 | 2017-06-20 | Baker Hughes Incorporated | Method of using sophorolipids or mannosylerythritol lipids as acid corrosion inhibitors in well treatment operations |
| US9725986B2 (en) | 2014-08-01 | 2017-08-08 | Multi-Chem Group, Llc | Multi-functional surfactant complexes for use in subterranean formations |
| US20170226398A1 (en)* | 2014-06-30 | 2017-08-10 | Oji Holdings Corporation | Composition containing minute cellulose fibers |
| US9884986B2 (en) | 2014-04-21 | 2018-02-06 | Baker Hughes, A Ge Company, Llc | Method of using biosurfactants as acid corrosion inhibitors in well treatment operations |
| WO2018049182A2 (en) | 2016-09-08 | 2018-03-15 | Locus Solutions, Llc | Distributed systems for the efficient production and use of microbe-based compositions |
| WO2018107162A1 (en) | 2016-12-11 | 2018-06-14 | Locus Solutions, Llc | Microbial products and their use in bioremediation and to remove paraffin and other contaminating substances from oil and gas production and processing equipment |
| WO2018129299A1 (en) | 2017-01-06 | 2018-07-12 | Locus Solutions, Llc | Novel fermentation systems and methods |
| US10023787B2 (en) | 2014-12-04 | 2018-07-17 | Halliburton Energy Services, Inc. | Surfactant selection methods for fluid recovery in subterranean formations |
| US20180201531A1 (en) | 2014-07-02 | 2018-07-19 | Mekorot Water Company, Ltd | A method for bioremediation of contaminated water |
| CN108373912A (en) | 2018-02-02 | 2018-08-07 | 中国石油化工股份有限公司华北油气分公司石油工程技术研究院 | A kind of salt-resisting high-temperature-resisting foam discharging agent and preparation method thereof |
| WO2018148397A2 (en) | 2017-02-09 | 2018-08-16 | Locus Oil Ip Company, Llc | Compositions and methods for reducing hydrogen sulfide and microbial influenced corrosion in crude oil, natural gas, and in associated equipment |
| WO2018148265A2 (en) | 2017-02-07 | 2018-08-16 | Locus Oil Ip Company, Llc | Materials and methods for reducing viscosity of oil |
| WO2018160995A1 (en) | 2017-03-03 | 2018-09-07 | Locus Oil Ip Company, Llc | Composition and methods for microbial enhanced digestion of polymers in fracking wells |
| US20180282608A1 (en) | 2015-09-30 | 2018-10-04 | Smi Oilfield Equipment And Products Fze | Oilfield deposit dispersant and dispersion method |
| WO2018191172A1 (en) | 2017-04-09 | 2018-10-18 | Locus Oil Ip Company, Llc | Microbial products and uses thereof to improve oil recovery |
| WO2018231791A1 (en) | 2017-06-12 | 2018-12-20 | Locus Oil Ip Company, Llc | Remediation of rag layer and other disposable layers in oil tanks and storage equipment |
| WO2018237137A1 (en) | 2017-06-21 | 2018-12-27 | Locus Oil Ip Company, Llc | TREATMENT FOR THE VALORIZATION OF HEAVY RAW PETROLEUM |
| WO2019022996A1 (en) | 2017-07-27 | 2019-01-31 | Locus Oil Company, Llc | Improved methods of selective and non-selective plugging for water flooding in enhanced oil recovery |
| WO2019022998A1 (en) | 2017-07-26 | 2019-01-31 | Locus Oil Ip Company, Llc | Two-step process for microbial enhanced oil recovery |
| WO2019046183A1 (en) | 2017-08-27 | 2019-03-07 | Locus Oil Ip Company, Llc | Symbiotic fermentation of acinetobacter and bacillus and applications thereof |
| WO2019067356A1 (en) | 2017-09-27 | 2019-04-04 | Locus Oil Ip Company, Llc | Materials and methods for recovering oil from oil sands |
| WO2019089730A1 (en) | 2017-10-31 | 2019-05-09 | Locus Ip Company, Llc | Matrix fermentation systems and methods for producing microbe-based products |
| WO2019094615A1 (en) | 2017-11-08 | 2019-05-16 | Locus Oil Ip Company, Llc | Multifunctional composition for enhanced oil recovery, improved oil quality and prevention of corrosion |
| WO2019133555A1 (en) | 2017-12-28 | 2019-07-04 | Locus Ip Company, Llc | Reactors and submerged fermentation methods for producing microbe-based products |
| US20190292436A1 (en) | 2015-12-18 | 2019-09-26 | Sabre Intellectual Property Holdings Llc | Chlorine Dioxide Containing Mixtures And Chlorine Dioxide Bulk Treatments For Enhancing Oil And Gas Recovery |
| WO2019191296A1 (en) | 2018-03-27 | 2019-10-03 | Locus Oil Ip Company, Llc | Multi-functional compositions for enhanced oil and gas recovery and other petroleum industry applications |
| US20190309208A1 (en)* | 2016-01-14 | 2019-10-10 | Novogy, Inc. | Engineered Lubricant |
| WO2019200054A1 (en) | 2018-04-11 | 2019-10-17 | Locus Ip Company, Llc | Production of anaerobic microorganisms using viscosified nutrient medium |
| WO2019204715A1 (en) | 2018-04-19 | 2019-10-24 | Locus Oil Ip Company, Llc | Compositions and methods for removing sludge from oil storage tanks |
| WO2019222168A1 (en) | 2018-05-14 | 2019-11-21 | Locus Ip Company, Llc | Production and preservation of bacillus reference culture for generating standardized and reliable inocula |
| US20190359562A1 (en) | 2017-02-10 | 2019-11-28 | Lawrence Livermore National Security, Llc | Biodegradable surfactants and related compositions, methods and systems |
| WO2020006194A1 (en) | 2018-06-29 | 2020-01-02 | Locus Ip Company, Llc | Method and apparatus for continuous production of sophorolipids |
Family Cites Families (4)
| Publication number | Priority date | Publication date | Assignee | Title |
|---|---|---|---|---|
| WO2009155442A1 (en)* | 2008-06-18 | 2009-12-23 | Micro Pure Solutions, Llc | A composition comprising peroxygen and surfactant compounds and method of using the same |
| DE102009046215A1 (en)* | 2009-10-30 | 2011-05-12 | Henkel Ag & Co. Kgaa | Antimicrobial cleaner for hard surfaces |
| US11434415B2 (en)* | 2018-04-30 | 2022-09-06 | Locus Oil Ip Company, Llc | Compositions and methods for paraffin liquefaction and enhanced oil recovery in oil wells and associated equipment |
| US11447684B2 (en)* | 2018-08-20 | 2022-09-20 | Locus Oil Ip Company, Llc | Methods for paraffin removal and extended post-primary oil recovery |
- 2019
- 2019-04-30USUS17/052,181patent/US11434415B2/enactiveActive
- 2019-04-30WOPCT/US2019/029870patent/WO2019213055A1/ennot_activeCeased
- 2019-04-30CACA3098893Apatent/CA3098893A1/enactivePending
- 2022
- 2022-07-30USUS17/877,902patent/US11891567B2/enactiveActive
- 2024
- 2024-01-22USUS18/418,547patent/US12173230B2/enactiveActive
- 2024-12-24USUS19/000,993patent/US20250129287A1/enactivePending
Patent Citations (132)
| Publication number | Priority date | Publication date | Assignee | Title |
|---|---|---|---|---|
| US3191676A (en) | 1962-11-14 | 1965-06-29 | Pan American Petroleum Corp | Use of phosphates in a waterflooding process |
| US3581824A (en) | 1969-12-17 | 1971-06-01 | Mobil Oil Corp | Oil recovery process using an ionic polysaccharide thickening agent |
| US3871956A (en) | 1970-06-03 | 1975-03-18 | Bioteknika International | Microbial degradation of petroleum |
| US4369125A (en) | 1977-09-12 | 1983-01-18 | C E C A-S.A. | Gelling compositions having a base of galactomannans and xanthan |
| US4450908A (en) | 1982-04-30 | 1984-05-29 | Phillips Petroleum Company | Enhanced oil recovery process using microorganisms |
| US5152907A (en) | 1982-09-28 | 1992-10-06 | Amoco Corporation | Solvent systems for use in oil and gas wells |
| US4487262A (en) | 1982-12-22 | 1984-12-11 | Mobil Oil Corporation | Drive for heavy oil recovery |
| US4522261A (en) | 1983-04-05 | 1985-06-11 | The Board Of Regents For The University Of Oklahoma | Biosurfactant and enhanced oil recovery |
| US4561501A (en) | 1983-06-28 | 1985-12-31 | Phillips Petroleum Company | Surfactant oil recovery systems and recovery of oil therewith |
| US4793826A (en) | 1984-09-24 | 1988-12-27 | Petroleum Fermentations N.V. | Bioemulsifier-stabilized hydrocarbosols |
| US5156652A (en) | 1986-12-05 | 1992-10-20 | Canadian Occidental Petroleum Ltd. | Low-temperature pipeline emulsion transportation enhancement |
| US4905761A (en) | 1988-07-29 | 1990-03-06 | Iit Research Institute | Microbial enhanced oil recovery and compositions therefor |
| US5284576A (en) | 1989-08-01 | 1994-02-08 | Petrolite Corporation | Method of scavenging hydrogen sulfide from hydrocarbons |
| US5165477A (en) | 1990-12-21 | 1992-11-24 | Phillips Petroleum Company | Enzymatic decomposition of drilling mud |
| US6033901A (en) | 1994-04-11 | 2000-03-07 | Aplc, Inc. | System and process for in tank treatment of crude oil sludges to recover hydrocarbons and aid in materials separation |
| US5869325A (en) | 1996-03-22 | 1999-02-09 | Atlantic Richfield Company | Use of bacteria to break gels used in well treatment fluids |
| US20010056047A1 (en) | 2000-03-28 | 2001-12-27 | Georg Meine | Cleaning of fruit, vegetables, and meats |
| US20040171512A1 (en) | 2001-06-27 | 2004-09-02 | Taro Furuta | Low-foaming detergent compositions |
| US6942037B1 (en) | 2002-08-15 | 2005-09-13 | Clariant Finance (Bvi) Limited | Process for mitigation of wellbore contaminants |
| US20040231845A1 (en) | 2003-05-15 | 2004-11-25 | Cooke Claude E. | Applications of degradable polymers in wells |
| US20070092930A1 (en) | 2003-07-14 | 2007-04-26 | The Energy And Resources Institute | Process for enhanced recovery of crude oil from oil wells using novel microbial consortium |
| US7216705B2 (en)* | 2005-02-22 | 2007-05-15 | Halliburton Energy Services, Inc. | Methods of placing treatment chemicals |
| US20070151726A1 (en) | 2005-03-16 | 2007-07-05 | Baker Hughes Incorporated | Methods and Compositions for Diverting Acid Fluids in Wellbores |
| US20060219409A1 (en) | 2005-03-29 | 2006-10-05 | Dyer Richard J | Method for simultaneous removal of asphaltine, and/or paraffin and scale from producing oil wells |
| US20070125536A1 (en) | 2005-12-07 | 2007-06-07 | Andrew Acock | Method to Improve the Injectivity of Fluids and Gases Using Hydraulic Fracturing |
| WO2007129332A1 (en) | 2006-05-05 | 2007-11-15 | Halliburton Energy Services, Inc. | Compositions and methods for removal of asphaltenes from a portion of a wellbore or subterranean formation |
| US7677673B2 (en) | 2006-09-26 | 2010-03-16 | Hw Advanced Technologies, Inc. | Stimulation and recovery of heavy hydrocarbon fluids |
| US20080139412A1 (en)* | 2006-12-06 | 2008-06-12 | Fuller Michael J | Method for Treating a Subterranean Formation |
| US20080167445A1 (en) | 2007-01-04 | 2008-07-10 | Carl Walter Podella | Enhanced oil recovery compositions comprising proteins and surfactants and methods of using the same |
| US20080280789A1 (en) | 2007-05-10 | 2008-11-13 | Halliburton Energy Services, Inc. | Methods for stimulating oil or gas production using a viscosified aqueous fluid with a chelating agent to remove scale from wellbore tubulars or subsurface equipment |
| GB2450204A (en) | 2007-05-11 | 2008-12-17 | Clearwater Int Llc | Reducing the viscosity of a fracturing fluid using microbes |
| US20080302531A1 (en) | 2007-06-09 | 2008-12-11 | Oil Chem Technologies | Process for recovering oil from subterranean reservoirs |
| US7681638B2 (en) | 2007-06-15 | 2010-03-23 | Glori Oil Limited | Wellbore treatment for reducing wax deposits |
| US20100163230A1 (en) | 2007-06-26 | 2010-07-01 | Hans Kristian Kotlar | Method of enhancing oil recovery |
| US20090029879A1 (en) | 2007-07-12 | 2009-01-29 | Glori Oil Limited | Process for enhanced oil recovery using a microbial consortium |
| US7472747B1 (en) | 2007-08-01 | 2009-01-06 | Savannah River Nuclear Solutions, Llc | Biological enhancement of hydrocarbon extraction |
| US20100044031A1 (en) | 2008-08-20 | 2010-02-25 | E. I. Dupont De Nemours And Company | Method for identification of novel anaerobic denitrifying bacteria utilizing petroleum components as sole carbon source |
| JP2010200695A (en) | 2009-03-04 | 2010-09-16 | National Institute Of Advanced Industrial Science & Technology | Method for producing biosurfactant |
| WO2010111226A2 (en) | 2009-03-23 | 2010-09-30 | Yale University Office Of Cooperative Research | A composition and method for inhibiting agglomeration of hydrates in pipelines |
| WO2011008570A2 (en) | 2009-07-16 | 2011-01-20 | Dow Global Technologies, Inc. | Sulfonate surfactants and methods of preparation and use |
| US8316933B2 (en) | 2009-08-28 | 2012-11-27 | Geo Fossil Fuels Llc | Microbial enhanced oil recovery methods |
| US8188012B2 (en) | 2009-09-10 | 2012-05-29 | Board Of Regents, The University Of Texas System | Process of using hard brine at high alkalinity for enhanced oil recovery (EOR) applications |
| US20110139262A1 (en) | 2009-12-15 | 2011-06-16 | Instituto Mexicano Del Petroleo | Process of preparing improved heavy and extra heavy crude oil emulsions by use of biosurfactants in water and product thereof |
| US20120055685A1 (en) | 2010-05-21 | 2012-03-08 | James Kenneth Sanders | Methods for increasing oil production |
| US20110290482A1 (en) | 2010-05-25 | 2011-12-01 | Board Of Regents, The University Of Texas System | Surfactant-Less Alkaline-Polymer Formulations for Recovering Reactive Crude Oil |
| US20120037368A1 (en) | 2010-08-12 | 2012-02-16 | Conocophillips Company | Controlled release proppant |
| US20130319656A1 (en) | 2010-10-06 | 2013-12-05 | Trican Well Service Ltd. | Enzyme breakers and methods for fluid systems |
| US20120122740A1 (en) | 2010-11-12 | 2012-05-17 | Instituto Mexicano Del Petroleo | Heavy oil recovery process using extremophile anaerobic indigenous microorganisms |
| US20120292022A1 (en) | 2010-11-22 | 2012-11-22 | E. I. Du Pont De Nemours And Company | Composition for improving oil recovery including n-lauroyl amino acid-based compounds and microbes |
| US20130264060A1 (en) | 2010-12-17 | 2013-10-10 | Akzo Nobel Chemicals International B.V. | Fluid suitable for treatment of carbonate formations containing a chelating agent |
| US20130062053A1 (en) | 2011-02-25 | 2013-03-14 | William J. Kohr | Alkaline microbial enhanced oil recovery |
| US20120247763A1 (en)* | 2011-04-01 | 2012-10-04 | Solazyme, Inc. | Biomass-based oil field chemicals |
| US20130020082A1 (en) | 2011-04-05 | 2013-01-24 | Lumsden Charles A | Method and compositions for enhanced oil recovery |
| US20140073541A1 (en) | 2011-05-16 | 2014-03-13 | Stepan Company | Surfactants for enhanced oil recovery |
| CN102352227A (en) | 2011-08-08 | 2012-02-15 | 中国海洋石油总公司 | Lipopeptide biosurfactant, preparation method thereof, and application thereof |
| US20130048282A1 (en)* | 2011-08-23 | 2013-02-28 | David M. Adams | Fracturing Process to Enhance Propping Agent Distribution to Maximize Connectivity Between the Formation and the Wellbore |
| US9422470B2 (en) | 2011-09-15 | 2016-08-23 | Multi-Chem Group, Llc | Method for selection of surfactants in well stimulation |
| CN102399547A (en) | 2011-10-31 | 2012-04-04 | 湖州紫金生物科技有限公司 | Application of rhamnolipid as crude oil pipeline drag reducer and viscosity reducer |
| US9441115B2 (en) | 2011-11-14 | 2016-09-13 | Tantz Environmental Technologies Ltd. | Aqueous phase pore sealing agent imroving PCB coating oxidation-resistant and corrosion-resistant properties and method for using same |
| US20140332212A1 (en)* | 2011-11-30 | 2014-11-13 | Verutek Technologies, Inc. | Compositions and methods for enhanced hydrocarbon recovery |
| WO2013110132A1 (en) | 2012-01-27 | 2013-08-01 | Gfs Corporation Aus Pty Ltd | Method of producing biosurfactants |
| US20150037302A1 (en) | 2012-01-27 | 2015-02-05 | Gfs Corporation Aus Pty Ltd | Method of producing biosurfactants |
| US20140305649A1 (en)* | 2012-04-12 | 2014-10-16 | Hongxin Tang | Submicron particles surfactant method for improved oil recovery from subterranean reservoirs |
| WO2013157921A1 (en) | 2012-04-20 | 2013-10-24 | Bci Chemical Corporation Sdn. Bhd. | Oil recovery from oil sludge with nanoemulsion surfactant |
| US20150068950A1 (en) | 2012-04-20 | 2015-03-12 | Bci Chemical Corporation Sdn. Bhd. | Method of removing oil sludge and recovering oil from oil sludge with nanoemulsion surfactant system |
| CN103449696A (en) | 2012-06-04 | 2013-12-18 | 江苏博大环保股份有限公司 | Method for improving oil sludge separating and processing efficiency and bacterial strain used for method |
| CN102925397A (en) | 2012-11-23 | 2013-02-13 | 天津亿利科能源科技发展股份有限公司 | Mixed bacterial agent for reducing viscosity of thick oil, as well as preparation method and use thereof |
| US20140256600A1 (en)* | 2013-03-08 | 2014-09-11 | Solazyme, Inc. | Oleaginous Microbial Lubricants |
| US20160244347A1 (en) | 2013-03-15 | 2016-08-25 | Janet Angel | Composition and Methods of Use |
| WO2014152350A1 (en) | 2013-03-15 | 2014-09-25 | Angel Janet | Composition and methods of use |
| US20140273150A1 (en) | 2013-03-15 | 2014-09-18 | Janet Angel | Compositions and Methods of Use |
| US20140315765A1 (en) | 2013-04-22 | 2014-10-23 | Hulliburton Energy Services, Inc. | Treatment of a subterranean formation with composition including a microorganism or compound generated by the same |
| US20140323757A1 (en) | 2013-04-30 | 2014-10-30 | Gyeongbuk Institute of Marine Bio-industry | Biosurfactant Isolated from Yeast |
| US20140360727A1 (en) | 2013-06-07 | 2014-12-11 | Shell Oil Company | Remediation of asphaltene-induced plugging of an oil-bearing formation |
| US20160145487A1 (en) | 2013-09-11 | 2016-05-26 | Halliburton Energy Services, Inc. | Asphaltene-dissolving oil-external emulsion for acidization and methods of using the same |
| US20160222280A1 (en) | 2013-09-12 | 2016-08-04 | Geo Fossil Fuels, Llc | Microbial enhanced oil recovery method |
| US20160251565A1 (en) | 2013-11-05 | 2016-09-01 | Kaneka Corporation | Method for producing hydrocarbon fluid from hydrocarbon fluid-rich shale |
| CN103614131A (en) | 2013-12-12 | 2014-03-05 | 大连奥普森生物工程有限公司 | Biochemical anti-salt anti-high temperature oil displacement viscosity reducer and preparation method thereof |
| CN103614131B (en) | 2013-12-12 | 2016-01-13 | 大连奥普森生物工程有限公司 | A kind of Biochemical anti-salt anti-high temperature oil displacement viscosity reducer and preparation method thereof |
| US20160160111A1 (en) | 2013-12-13 | 2016-06-09 | Halliburton Energy Services, Inc. | Methods and systems for removing geothermal scale |
| WO2015093934A1 (en) | 2013-12-19 | 2015-06-25 | Bci Chemical Corporation Sdn Bhd | A method of treating oily solid particles |
| US20150259642A1 (en) | 2014-03-06 | 2015-09-17 | Indian Institute Of Technology Madras | Methods and compositions for degrading oil sludge |
| KR101481459B1 (en) | 2014-03-07 | 2015-01-13 | 한국지질자원연구원 | Bitumen mining method of oil sand using biological treatment |
| US9884986B2 (en) | 2014-04-21 | 2018-02-06 | Baker Hughes, A Ge Company, Llc | Method of using biosurfactants as acid corrosion inhibitors in well treatment operations |
| US20150300139A1 (en) | 2014-04-21 | 2015-10-22 | Baker Hughes Incorporated | Method of using sophorolipids in well treatment operations |
| US10190038B2 (en) | 2014-04-21 | 2019-01-29 | Baker Hughes, A Ge Company, Llc | Method of using sophorolipids in well treatment operations |
| US9683164B2 (en) | 2014-04-21 | 2017-06-20 | Baker Hughes Incorporated | Method of using sophorolipids or mannosylerythritol lipids as acid corrosion inhibitors in well treatment operations |
| WO2015167864A1 (en) | 2014-05-01 | 2015-11-05 | Exxonmobil Research And Engineering Company | Method and system of upgrading heavy oils in the presence of hydrogen and a dispersed catalyst |
| US20170037301A1 (en) | 2014-05-30 | 2017-02-09 | Halliburton Energy Services, Inc. | Polymeric surfactant containing a protein head group and lipid tail group |
| JP2016000017A (en) | 2014-06-12 | 2016-01-07 | 花王株式会社 | Method of producing sophorolipid |
| CN104109646A (en) | 2014-06-23 | 2014-10-22 | 中国石油化工股份有限公司 | Slime reducing agent suitable for heavy oil wells with different mineralization and application |
| US20170226398A1 (en)* | 2014-06-30 | 2017-08-10 | Oji Holdings Corporation | Composition containing minute cellulose fibers |
| US20180201531A1 (en) | 2014-07-02 | 2018-07-19 | Mekorot Water Company, Ltd | A method for bioremediation of contaminated water |
| US20160002521A1 (en)* | 2014-07-03 | 2016-01-07 | Solazyme, Inc. | Lubricants and wellbore fluids |
| US9550937B2 (en) | 2014-07-31 | 2017-01-24 | Baker Hughes Incorporated | Methods and compositions for decreasing the viscosity of hydrocarbon-based fluids during refining |
| US9725986B2 (en) | 2014-08-01 | 2017-08-08 | Multi-Chem Group, Llc | Multi-functional surfactant complexes for use in subterranean formations |
| US10023787B2 (en) | 2014-12-04 | 2018-07-17 | Halliburton Energy Services, Inc. | Surfactant selection methods for fluid recovery in subterranean formations |
| US20160333258A1 (en) | 2015-05-13 | 2016-11-17 | Preferred Technology, Llc | Hydrophobic Coating of Particulates for Enhanced Well Productivity |
| CN104974952A (en) | 2015-05-29 | 2015-10-14 | 苏州泽方新能源技术有限公司 | Mixed bacteria producing biological surfactant, and screening method thereof |
| WO2016196680A1 (en) | 2015-06-01 | 2016-12-08 | Robert Caron | Biofilm control and frack fluid production using bacillus subtilis activated with gfak |
| WO2017040903A1 (en) | 2015-09-02 | 2017-03-09 | Chevron U.S.A. Inc. | Enhanced oil recovery compositions and methods thereof |
| WO2017044953A1 (en) | 2015-09-10 | 2017-03-16 | Locus Solutions, Llc | Enhanced microbial production of biosurfactants and other products, and uses thereof |
| US20180282608A1 (en) | 2015-09-30 | 2018-10-04 | Smi Oilfield Equipment And Products Fze | Oilfield deposit dispersant and dispersion method |
| US20170138135A1 (en) | 2015-11-18 | 2017-05-18 | Meshari Almutairi | System and method for remediation of oil-contaminated sand |
| US20190292436A1 (en) | 2015-12-18 | 2019-09-26 | Sabre Intellectual Property Holdings Llc | Chlorine Dioxide Containing Mixtures And Chlorine Dioxide Bulk Treatments For Enhancing Oil And Gas Recovery |
| US20190309208A1 (en)* | 2016-01-14 | 2019-10-10 | Novogy, Inc. | Engineered Lubricant |
| CN105753283A (en) | 2016-03-14 | 2016-07-13 | 北京华纳斯科技有限公司 | Method of utilizing biosurfactant and microbial agent to treat oil-containing sediment |
| WO2018049182A2 (en) | 2016-09-08 | 2018-03-15 | Locus Solutions, Llc | Distributed systems for the efficient production and use of microbe-based compositions |
| US20190218499A1 (en)* | 2016-09-08 | 2019-07-18 | Locus Ip Company, Llc | Distributed systems for the efficient production and use of microbe-based compositions |
| WO2018107162A1 (en) | 2016-12-11 | 2018-06-14 | Locus Solutions, Llc | Microbial products and their use in bioremediation and to remove paraffin and other contaminating substances from oil and gas production and processing equipment |
| WO2018129299A1 (en) | 2017-01-06 | 2018-07-12 | Locus Solutions, Llc | Novel fermentation systems and methods |
| WO2018148265A2 (en) | 2017-02-07 | 2018-08-16 | Locus Oil Ip Company, Llc | Materials and methods for reducing viscosity of oil |
| WO2018148397A3 (en) | 2017-02-09 | 2018-11-01 | Locus Oil Ip Company, Llc | Compositions and methods for reducing hydrogen sulfide and microbial influenced corrosion in crude oil, natural gas, and in associated equipment |
| WO2018148397A2 (en) | 2017-02-09 | 2018-08-16 | Locus Oil Ip Company, Llc | Compositions and methods for reducing hydrogen sulfide and microbial influenced corrosion in crude oil, natural gas, and in associated equipment |
| US20190359562A1 (en) | 2017-02-10 | 2019-11-28 | Lawrence Livermore National Security, Llc | Biodegradable surfactants and related compositions, methods and systems |
| WO2018160995A1 (en) | 2017-03-03 | 2018-09-07 | Locus Oil Ip Company, Llc | Composition and methods for microbial enhanced digestion of polymers in fracking wells |
| WO2018191172A1 (en) | 2017-04-09 | 2018-10-18 | Locus Oil Ip Company, Llc | Microbial products and uses thereof to improve oil recovery |
| WO2018231791A1 (en) | 2017-06-12 | 2018-12-20 | Locus Oil Ip Company, Llc | Remediation of rag layer and other disposable layers in oil tanks and storage equipment |
| WO2018237137A1 (en) | 2017-06-21 | 2018-12-27 | Locus Oil Ip Company, Llc | TREATMENT FOR THE VALORIZATION OF HEAVY RAW PETROLEUM |
| WO2019022998A1 (en) | 2017-07-26 | 2019-01-31 | Locus Oil Ip Company, Llc | Two-step process for microbial enhanced oil recovery |
| WO2019022996A1 (en) | 2017-07-27 | 2019-01-31 | Locus Oil Company, Llc | Improved methods of selective and non-selective plugging for water flooding in enhanced oil recovery |
| WO2019046183A1 (en) | 2017-08-27 | 2019-03-07 | Locus Oil Ip Company, Llc | Symbiotic fermentation of acinetobacter and bacillus and applications thereof |
| WO2019067356A1 (en) | 2017-09-27 | 2019-04-04 | Locus Oil Ip Company, Llc | Materials and methods for recovering oil from oil sands |
| WO2019089730A1 (en) | 2017-10-31 | 2019-05-09 | Locus Ip Company, Llc | Matrix fermentation systems and methods for producing microbe-based products |
| WO2019094615A1 (en) | 2017-11-08 | 2019-05-16 | Locus Oil Ip Company, Llc | Multifunctional composition for enhanced oil recovery, improved oil quality and prevention of corrosion |
| WO2019133555A1 (en) | 2017-12-28 | 2019-07-04 | Locus Ip Company, Llc | Reactors and submerged fermentation methods for producing microbe-based products |
| CN108373912A (en) | 2018-02-02 | 2018-08-07 | 中国石油化工股份有限公司华北油气分公司石油工程技术研究院 | A kind of salt-resisting high-temperature-resisting foam discharging agent and preparation method thereof |
| WO2019191296A1 (en) | 2018-03-27 | 2019-10-03 | Locus Oil Ip Company, Llc | Multi-functional compositions for enhanced oil and gas recovery and other petroleum industry applications |
| WO2019200054A1 (en) | 2018-04-11 | 2019-10-17 | Locus Ip Company, Llc | Production of anaerobic microorganisms using viscosified nutrient medium |
| WO2019204715A1 (en) | 2018-04-19 | 2019-10-24 | Locus Oil Ip Company, Llc | Compositions and methods for removing sludge from oil storage tanks |
| WO2019222168A1 (en) | 2018-05-14 | 2019-11-21 | Locus Ip Company, Llc | Production and preservation of bacillus reference culture for generating standardized and reliable inocula |
| WO2020006194A1 (en) | 2018-06-29 | 2020-01-02 | Locus Ip Company, Llc | Method and apparatus for continuous production of sophorolipids |
Non-Patent Citations (30)
Cited By (4)
| Publication number | Priority date | Publication date | Assignee | Title |
|---|---|---|---|---|
| US20220372364A1 (en)* | 2018-04-30 | 2022-11-24 | Locus Oil Ip Company, Llc | Compositions and Methods for Paraffin Liquefaction and Enhanced Oil Recovery in Oil Wells and Associated Equipment |
| US11891567B2 (en)* | 2018-04-30 | 2024-02-06 | Locus Solutions Ipco, Llc | Compositions and methods for paraffin liquefaction and enhanced oil recovery in oil wells and associated equipment |
| US20240218240A1 (en)* | 2018-04-30 | 2024-07-04 | Locus Solutions Ipco, Llc | Compositions and Methods for Paraffin Liquefaction and Enhanced Oil Recovery in Oil Wells and Associated Equipment |
| US12173230B2 (en)* | 2018-04-30 | 2024-12-24 | Locus Solutions Ipco, Llc | Compositions and methods for paraffin liquefaction and enhanced oil recovery in oil wells and associated equipment |
Also Published As
| Publication number | Publication date |
|---|---|
| US20250129287A1 (en) | 2025-04-24 |
| US20220372364A1 (en) | 2022-11-24 |
| US20240218240A1 (en) | 2024-07-04 |
| CA3098893A1 (en) | 2019-11-07 |
| US11891567B2 (en) | 2024-02-06 |
| US12173230B2 (en) | 2024-12-24 |
| WO2019213055A1 (en) | 2019-11-07 |
| US20210301191A1 (en) | 2021-09-30 |
Similar Documents
| Publication | Publication Date | Title |
|---|---|---|
| US12173230B2 (en) | Compositions and methods for paraffin liquefaction and enhanced oil recovery in oil wells and associated equipment | |
| US11447684B2 (en) | Methods for paraffin removal and extended post-primary oil recovery | |
| US20240068019A1 (en) | Microbial Products and Their Use in Bioremediation and to Remove Paraffin and Other Contaminating Substances from Oil and Gas Production and Processing Equipment | |
| US11441082B2 (en) | Treatment for upgrading heavy crude oil | |
| WO2020264073A1 (en) | Compositions and methods for paraffin liquefaction and enhanced oil recovery using concentrated acids | |
| US12338391B2 (en) | Microbial surfactants to prevent and/or remove asphaltene deposits | |
| US11608465B2 (en) | Multi-functional compositions for enhanced oil and gas recovery and other petroleum industry applications | |
| US11807810B2 (en) | Multi-functional compositions comprising concentrated acids for enhanced oil and gas recovery | |
| WO2025015158A1 (en) | Microemulsion compositions for enhanced acidizing of oil and gas wells | |
| EA041311B1 (en) | PRODUCTS BASED ON MICROORGANISMS AND THEIR USE IN BIOREMEDIATION AND FOR THE REMOVAL OF PARAFFIN AND OTHER POLLUTANTS IN OIL AND GAS PRODUCTION AND FROM PROCESSING EQUIPMENT | |
| BR112019011720B1 (en) | COMPOSITION COMPRISING A WICKERHAMOMYCES ANOMALUS YEAST AND METHOD FOR SIMULTANEOUSLY IMPROVING OIL RECOVERY FROM AN OIL WELL IN THE REMOVAL OF CONTAMINANTS FROM OIL AND/OR GAS PRODUCTION OR PROCESSING EQUIPMENT |
Legal Events
| Date | Code | Title | Description |
|---|---|---|---|
| FEPP | Fee payment procedure | Free format text:ENTITY STATUS SET TO UNDISCOUNTED (ORIGINAL EVENT CODE: BIG.); ENTITY STATUS OF PATENT OWNER: SMALL ENTITY | |
| AS | Assignment | Owner name:LOCUS OIL IP COMPANY, LLC, OHIO Free format text:ASSIGNMENT OF ASSIGNORS INTEREST;ASSIGNORS:FARMER, SEAN;ALIBEK, KEN;NERRIS, ANTHONY;AND OTHERS;SIGNING DATES FROM 20190508 TO 20190802;REEL/FRAME:054268/0812 | |
| FEPP | Fee payment procedure | Free format text:ENTITY STATUS SET TO SMALL (ORIGINAL EVENT CODE: SMAL); ENTITY STATUS OF PATENT OWNER: SMALL ENTITY | |
| STPP | Information on status: patent application and granting procedure in general | Free format text:NON FINAL ACTION MAILED | |
| STPP | Information on status: patent application and granting procedure in general | Free format text:RESPONSE TO NON-FINAL OFFICE ACTION ENTERED AND FORWARDED TO EXAMINER | |
| STPP | Information on status: patent application and granting procedure in general | Free format text:NON FINAL ACTION MAILED | |
| STPP | Information on status: patent application and granting procedure in general | Free format text:RESPONSE TO NON-FINAL OFFICE ACTION ENTERED AND FORWARDED TO EXAMINER | |
| STPP | Information on status: patent application and granting procedure in general | Free format text:NOTICE OF ALLOWANCE MAILED -- APPLICATION RECEIVED IN OFFICE OF PUBLICATIONS | |
| STPP | Information on status: patent application and granting procedure in general | Free format text:AWAITING TC RESP., ISSUE FEE NOT PAID | |
| STPP | Information on status: patent application and granting procedure in general | Free format text:PUBLICATIONS -- ISSUE FEE PAYMENT VERIFIED | |
| STCF | Information on status: patent grant | Free format text:PATENTED CASE | |
| AS | Assignment | Owner name:LOCUS SOLUTIONS IPCO, LLC, OHIO Free format text:ASSIGNMENT OF ASSIGNORS INTEREST;ASSIGNOR:LOCUS OIL IP COMPANY, LLC;REEL/FRAME:061770/0855 Effective date:20221026 | |
| AS | Assignment | Owner name:LOCUS SOLUTIONS IPCO, LLC, OHIO Free format text:ASSIGNMENT OF ASSIGNORS INTEREST;ASSIGNOR:LOCUS OIL IP COMPANY, LLC;REEL/FRAME:061957/0435 Effective date:20221026 | |
| AS | Assignment | Owner name:U.S. BANK TRUST COMPANY, NATIONAL ASSOCIATION, AS COLLATERAL AGENT, NORTH CAROLINA Free format text:SECURITY INTEREST;ASSIGNORS:LOCUS SOLUTIONS, LLC;LOCUS MANAGEMENT GP, INC.;LOCUS MANAGEMENT, LLC;AND OTHERS;REEL/FRAME:062079/0829 Effective date:20221026 | |
| AS | Assignment | Owner name:LOCUS SOLUTIONS IPCO, LLC, OHIO Free format text:ASSIGNMENT OF ASSIGNORS INTEREST;ASSIGNOR:LOCUS OIL IP COMPANY, LLC;REEL/FRAME:065615/0778 Effective date:20221026 | |
| AS | Assignment | Owner name:U.S. BANK TRUST COMPANY, NATIONAL ASSOCIATION, AS THE COLLATERAL AGENT, NORTH CAROLINA Free format text:SECURITY INTEREST;ASSIGNOR:LOCUS SOLUTIONS IPCO, LLC;REEL/FRAME:065836/0868 Effective date:20231130 | |
| AS | Assignment | Owner name:LOCUS SOLUTIONS IPCO, LLC, OHIO Free format text:RELEASE BY SECURED PARTY;ASSIGNOR:U.S. BANK TRUST COMPANY, NATIONAL ASSOCIATION, AS COLLATERAL AGENT;REEL/FRAME:069273/0361 Effective date:20241025 | |
| AS | Assignment | Owner name:U.S. BANK TRUST COMPANY, NATIONAL ASSOCIATION, AS COLLATERAL AGENT, NORTH CAROLINA Free format text:SECURITY INTEREST;ASSIGNOR:LOCUS SOLUTIONS IPCO, LLC;REEL/FRAME:069333/0911 Effective date:20241107 | |
| AS | Assignment | Owner name:ARCTIVA WELLNESS, LLC, OHIO Free format text:RELEASE BY SECURED PARTY;ASSIGNOR:U.S. BANK TRUST COMPANY;REEL/FRAME:069386/0272 Effective date:20241107 Owner name:LOCUS CONSUMER BRANDS HOLDING, LLC, OHIO Free format text:RELEASE BY SECURED PARTY;ASSIGNOR:U.S. BANK TRUST COMPANY;REEL/FRAME:069386/0272 Effective date:20241107 Owner name:LOCUS SOLUTIONS IPHOLDCO, LLC, OHIO Free format text:RELEASE BY SECURED PARTY;ASSIGNOR:U.S. BANK TRUST COMPANY;REEL/FRAME:069386/0272 Effective date:20241107 Owner name:LOCUS SOLUTIONS IPCO, LLC, DISTRICT OF COLUMBIA Free format text:RELEASE BY SECURED PARTY;ASSIGNOR:U.S. BANK TRUST COMPANY;REEL/FRAME:069386/0272 Effective date:20241107 Owner name:LOCUS AGRICULTURE IP COMPANY, LLC,, OHIO Free format text:RELEASE BY SECURED PARTY;ASSIGNOR:U.S. BANK TRUST COMPANY;REEL/FRAME:069386/0272 Effective date:20241107 Owner name:LOCUS AGRICULTURAL SOLUTIONS, LLC, OHIO Free format text:RELEASE BY SECURED PARTY;ASSIGNOR:U.S. BANK TRUST COMPANY;REEL/FRAME:069386/0272 Effective date:20241107 Owner name:LOCUS AGRICULTURE HOLDING, LLC, OHIO Free format text:RELEASE BY SECURED PARTY;ASSIGNOR:U.S. BANK TRUST COMPANY;REEL/FRAME:069386/0272 Effective date:20241107 Owner name:LOCUS OIL IP COMPANY, LLC, OHIO Free format text:RELEASE BY SECURED PARTY;ASSIGNOR:U.S. BANK TRUST COMPANY;REEL/FRAME:069386/0272 Effective date:20241107 Owner name:LOCUS BIO-ENERGY SOLUTIONS, LLC, OHIO Free format text:RELEASE BY SECURED PARTY;ASSIGNOR:U.S. BANK TRUST COMPANY;REEL/FRAME:069386/0272 Effective date:20241107 Owner name:LOCUS OIL HOLDING, LLC,, OHIO Free format text:RELEASE BY SECURED PARTY;ASSIGNOR:U.S. BANK TRUST COMPANY;REEL/FRAME:069386/0272 Effective date:20241107 Owner name:LOCUS IP COMPANY, LLC, OHIO Free format text:RELEASE BY SECURED PARTY;ASSIGNOR:U.S. BANK TRUST COMPANY;REEL/FRAME:069386/0272 Effective date:20241107 Owner name:LOCUS MANAGEMENT, LLC, OHIO Free format text:RELEASE BY SECURED PARTY;ASSIGNOR:U.S. BANK TRUST COMPANY;REEL/FRAME:069386/0272 Effective date:20241107 Owner name:LOCUS MANAGEMENT GP, INC., OHIO Free format text:RELEASE BY SECURED PARTY;ASSIGNOR:U.S. BANK TRUST COMPANY;REEL/FRAME:069386/0272 Effective date:20241107 Owner name:LOCUS SOLUTIONS, LLC, OHIO Free format text:RELEASE BY SECURED PARTY;ASSIGNOR:U.S. BANK TRUST COMPANY;REEL/FRAME:069386/0272 Effective date:20241107 |